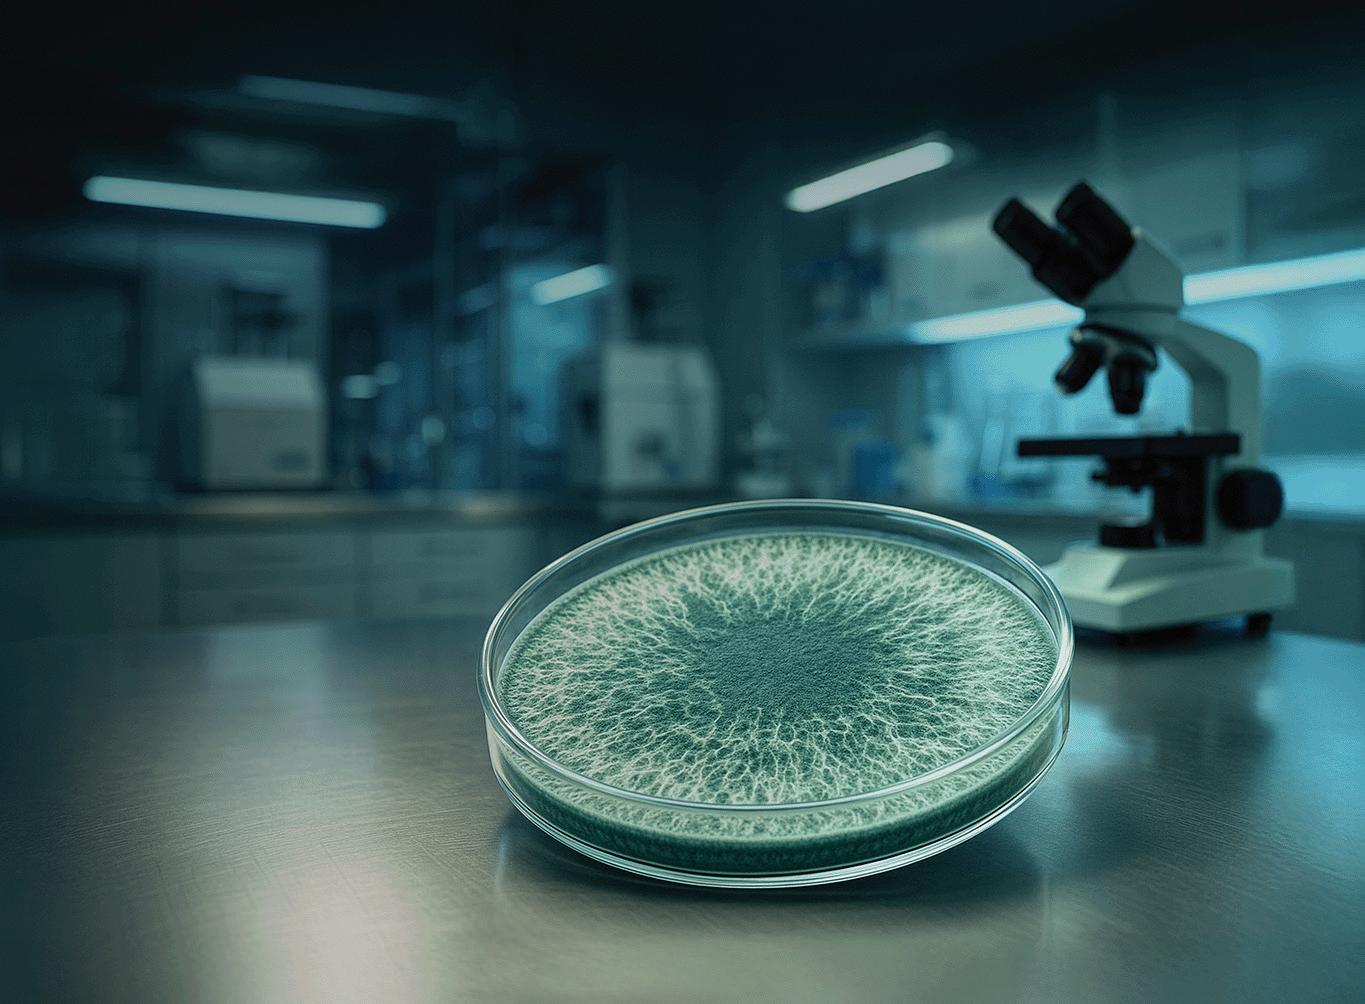

Para quem pensa, decide e vive o agribusiness

venda proibida distribuição dirigida www.plantproject.com.br
![]()
Para quem pensa, decide e vive o agribusiness

venda proibida distribuição dirigida www.plantproject.com.br
Tecnologia e gestão reposicionam o setor como parte da solução climática
PLANT PROJECT celebra sua trajetória como protagonista das transformações do agro
PASTO CADA VEZ MAIS VERDE WEBSÉRIE TOP SUSTAINABLE LIVESTOCK REVELA OS CAMINHOS DA PRODUÇÃO SUSTENTÁVEL
O CAMPO DA INCLUSÃO PESSOAS COM DEFICIÊNCIA GANHAM ESPAÇO NAS LAVOURAS
UM PACTO PELA AMAZÔNIA O BRASIL LEVA À COP30 PROPOSTA DE CAPTAR US$ 125 BILHÕES PARA A PROTEÇÃO DAS FLORESTAS
O BRINDE É NOSSO Uísques brasileiros ganham reconhecimento internacional
SETORES PRESENTES: Agricultores e Pecuaristas, Finanças e Trading, Comércio e Serviços, Governo, Usinas, Insumos e muito mais.







Editorial

PLANT PROJECT chega à sua 50ª edição com a missão de continuar acompanhando de perto as grandes transformações do agronegócio brasileiro. Desde 2016, a revista tem registrado – e, muitas vezes, antecipado – movimentos que redesenharam o setor: da digitalização do campo ao avanço das práticas regenerativas, da profissionalização da gestão à entrada definitiva da agenda climática nas estratégias de negócios. Ao longo desse percurso, não apenas observamos essas mudanças, mas também ajudamos a colocá-las em debate, dando voz a empreendedores, cientistas, investidores, líderes rurais e jovens inovadores. Celebrar as 50 edições é reafirmar o compromisso de seguir adiante.
A reportagem de capa da edição 50 está em sintonia com esse movimento ao mostrar como a pecuária brasileira, por muito tempo alvo de críticas ambientais, passa por um processo de transformação que pode reposicionar o setor como parte da solução climática. A combinação de ciência, tecnologia e boas práticas de gestão vem aproximando produtores, empresas e pesquisadores em torno de um objetivo comum: aumentar a eficiência produtiva e reduzir impactos ambientais.
A pauta ambiental encontra eco na estreia da série Top Sustainable Livestock, dedicada a mostrar exemplos concretos de pecuária sustentável no Brasil. Exibida pelo canal Terra Viva, do Grupo Bandeirantes, ela é realizada por PLANT PROJECT em parceria com a Mesa Brasileira da Pecuária Sustentável. Em seu primeiro episódio, o programa contará a trajetória do Grupo Rovema, na Amazônia, que alia produtividade e preservação por meio de genética, nutrição e participação no mercado de créditos de carbono. Dividida em cinco episódios, Top Sustainable Livestock trará histórias que mostram que preservar e prosperar podem andar lado a lado.
A convergência desses três marcos – a capa sobre a pecuária sustentável, a estreia da série e o especial de 50 edições – reforça o propósito da PLANT PROJECT: ser testemunha e protagonista das transformações do agro, mostrando como o setor pode liderar a transição para uma economia de baixo carbono. Esse é o compromisso que seguimos renovando a cada edição.
Boa leitura.
Amauri Segalla Diretor Editorial
A Mesa Brasileira da Pecuária Sustentável atua como espaço de construção conjunta entre todos os elos da cadeia produtiva. Durante a COP30, apresentaremos nosso posicionamento em defesa da pecuária brasileira como parte da solução para o clima e a segurança alimentar, promovendo uma pecuária mais sustentável, inovadora e comprometida com soluções para os desafios globais.
Convidamos todos os atores do setor a se engajarem conosco nessa jornada









Saiba mais em: www.pecuariasustentavel.org.br Aponte a câmera para o QR Code

plantproject.com.br
Diretor Editorial
Amauri Segalla amauri.segalla@datagro.com
Diretor
Luiz Felipe Nastari
Comercial
Carlos Nunes carlos.nunes@plantproject.com.br
Sérgio Siqueira sergio.siqueira@plantproject.com.br João Carlos Fernandes joao.fernandes@plantproject.com.br
Tida Cunha tida.cunha@plantproject.com.br
Arte
Thaís Rodrigues (Direção de Arte) Andrea Vianna (in memorian – Projeto Gráfico)
Colaboradores
Texto: Alexandre Dantas, André Sollitto, Lucas Bresser, Mário Sérgio Venditti, Romualdo Venâncio e Ronaldo Luiz
Design: Bruno Tulini
Produção
Lau Borges
Revisão
Rosi Melo
Eventos
Luiz Felipe Nastari
Administração e Finanças
Cláudia Nastari
Sérgio Nunes publicidade@plantproject.com assinaturas@plantproject.com
Impressão e acabamento: Piffer Print
Crédito foto de Capa: ShutterStock

GLOBAL pág.8
AGRIBUSINESS g pág. 17 F FRONTEIRA r pág. 87 W WORLD FAIR pág. 97 S STARTAGRO pág. 103 M MARKETS pág. 114 rA ARTE pág. 91

Os produtos Supremax com Selo Mitigador de Gás Metano reduzem emissões e entregam alta performance para o seu rebanho.
MAIS GANHO DE PESO E CONVERSÃO ALIMENTAR

TECNOLOGIA PARA REDUZIR EMISSÕES



RESULTADOS COMPROVADOS NO CAMPO


Fale com nossos especialistas e leve a inovação para o seu rebanho.

Novas regras
Acordo entre Ucrânia e UE protege produtores locais e prevê alinhamento regulatório até 2028
O lado cosmopolita do agro






























9.749 pessoas em 33 comunidades com 1 certeza:































































































Guiados pelo compromisso com o planeta e as pessoas, buscamos no diálogo e na colaboração com a população as soluções para promover o desenvolvimento socioeconômico das comunidades do nosso entorno com a preservação da floresta e da biodiversidade na Amazônia. Assim nasceu o SOMAR, nosso programa de responsabilidade socioambiental.














Implementado em 2023 em parceria com a Earthworm Foundation e o apoio do Instituto Peabiru como uma evolução das nossas estratégias de gestão socioambiental na região, o SOMAR já propiciou importantes melhorias nas áreas de educação, infraestrutura, meio ambiente, saúde e bem-estar. E assim seguirá avançando – e provando, como acreditamos, que é possível criar valor sem destruir.























O lado cosmopolita do agro
EUROPA
Nova rodada de negociações redefine o comércio agrícola entre Ucrânia e União Europeia, com retorno de tarifas, salvaguardas para produtores locais e promessas de alinhamento regulatório até 2028
Desde 2022, com o início da invasão russa, a Ucrânia passou a direcionar suas exportações agrícolas segundo as chamadas Medidas Comerciais Autônomas (MCA), um pacote que eliminou todas as tarifas e cotas sobre produtos enviados à União Europeia. A iniciativa abriu caminho para que grãos, milho, ovos e aves ucranianos chegassem aos mercados europeus, garantindo recursos vitais ao esforço de guerra. Tratou-se de um acordo histórico, sem precedentes, que foi prorrogado uma vez, mas já se encerrou. Agora, uma nova rodada de negociações estabeleceu as bases para as futuras relações comerciais entre Kiev e o bloco europeu.
A principal mudança foi a reintrodução das tarifas sobre os produtos agrícolas ucranianos. A decisão veio após intensos protestos de agricultores europeus, que criticavam as Medidas Comerciais Autônomas sob o argumento de que a isenção de taxas deixava seus produtos em desvantagem frente às

mercadorias vindas da Ucrânia. As tarifas de importação voltarão a subir de forma significativa para diversos itens exportados por Kiev. Já os chamados produtos “sensíveis” – como ovos, açúcar, trigo, aves e mel – terão tratamento diferenciado: as cotas serão ampliadas de maneira mais modesta e os volumes finais continuarão abaixo dos patamares históricos de comércio.
Por outro lado, a Ucrânia se comprometeu a alinhar gradualmente seus padrões de produção agrícola aos da União Europeia até 2028, em áreas como bem-estar animal
e uso de pesticidas, além de aceitar avaliações anuais para monitorar o progresso. Essa concessão atende a uma das principais críticas dos produtores europeus, que alegavam enfrentar exigências regulatórias mais rigorosas do que os agricultores ucranianos.
Os agricultores europeus também ganharam proteção adicional com a inclusão de “cláusulas de salvaguarda”, que permitem aos Estados-membros ou à própria União Europeia impor tarifas de emergência sempre que um excesso de importações colocar em risco os mercados locais.
O novo acordo, fechado recentemente, foi classificado por especialistas como um meio-termo entre o regime de taxações vigente antes da guerra e o acesso irrestrito concedido à Ucrânia após a invasão. Para muitos analistas, representa uma solução mais realista e sustentável a longo prazo. Ainda assim, não houve consenso: Romênia, Polônia, Hungria, Eslováquia e Bulgária já manifestaram preocupações, alertando que as importações ucranianas continuam a ameaçar seus mercados internos. Em outras palavras, a disputa está longe de chegar ao fim.
Desde 1990, o governo dos Estados Unidos vinha adotando medidas específicas para apoiar agricultores negros, como forma de reduzir os efeitos do racismo estrutural e da desigualdade no campo. Esse quadro mudou sob a gestão Trump, que decidiu suspender de forma definitiva tais recursos, alegando que a questão da discriminação já estaria “resolvida”. Em julho, o Departamento de Agricultura anunciou que deixaria de usar a expressão “socialmente desfavorecido”, utilizada para identificar agricultores e pecuaristas submetidos a discriminação racial, étnica ou de
gênero, incluindo negros, hispânicos, nativos americanos e asiáticos. Sem esse critério, programas de apoio correm o risco de favorecer apenas fazendeiros brancos, alertam políticos democratas e lideranças do setor. A mudança ocorre em meio a disputas judiciais movidas por produtores brancos que alegam ser vítimas de “racismo reverso” – conceito amplamente rejeitado por especialistas. O impasse revela um dilema central: a redistribuição de recursos pode fragilizar justamente uma das parcelas mais vulneráveis da agricultura americana.

NOS ESTADOS UNIDOS:
3,3 milhões de produtores registrados no censo mais recente
Gênero
• 2,1 milhões de homens
• 1,2 milhão de mulheres
Origem étnica
• 112,3 mil hispânicos e latinos
• 56,3 mil indígenas
• 41,8 mil negros
• 22,7 mil asiáticos
Faixa etária
• 837,5 mil têm entre 55 e 64 anos (maior parcela)
• 57 mil têm até 25 anos (menor parcela)
Fonte: Censo Agrícola

HOLANDA
A rede Albert Heijn entrou para a história ao se tornar o primeiro supermercado global a divulgar suas taxas de emissão de metano –responsável por 14% de sua pegada de carbono – em seu mais recente relatório de sustentabilidade. A iniciativa aumentou a pressão de ambientalistas, como a organização Mighty Earth, para que outras redes adotem a mesma prática e comecem a traçar estratégias concre-
tas de redução. Um estudo da Greenpeace Nordic mostra que as emissões estimadas de metano de 29 grandes empresas de carne e laticínios rivalizam com as das 100 maiores petroleiras do mundo. Diante disso, ONGs defendem que os supermercados priorizem fornecedores certificados e comprometidos em cortar emissões, ajudando a reduzir os níveis de metano em toda a cadeia de abastecimento.


NOVA ZELÂNDIA
Presente em todas as folhas verdes – de algas a beterraba –, a proteína RuBisCO é considerada uma das mais abundantes do planeta e possui digestibilidade e funcionalidade comparáveis às das proteínas animais, como a do ovo e o soro de leite. O grande obstáculo, porém, sempre foi a dificuldade de isolá-la em quantidades viáveis. É justamente essa barreira que a Leaft Foods, startup da Nova Zelândia, busca superar. A empresa desenvolveu uma tecnolo-
gia que permite extrair a proteína a partir da alfafa, planta altamente produtiva. Após as folhas serem prensadas e moídas, o chamado “suco verde” passa por um processo de separação da clorofila e de outros componentes, resultando na obtenção de RuBisCO.
A inovação já possibilitou à Leaft Foods escalar a produção, atrair investidores e lançar no mercado uma versão voltada ao público final, especialmente atletas de alta performance.

No início dos anos 2000, a dupla de DJs Andy Cato e Tom Findlay sacudiu as pistas de dança inglesas com hits como Superstylin, que conquistou as paradas pela batida contagiante. Duas décadas depois, embora ainda produza música, Cato voltou suas atenções para um território bem diferente: o campo. Arrendatário de uma fazenda do National Trust, entidade dedicada à preservação da natureza e do patrimônio histórico, ele defende práticas agrícolas regenerativas. “Precisamos viver em um mundo onde a
agricultura e a alimentação sejam interessantes e aspiracionais”, disse em entrevista à BBC. Seu interesse pela vida no campo surgiu de forma inusitada, ao receber um panfleto sobre segurança alimentar no retorno de um show. A leitura o motivou a comprar uma fazenda na França, onde enfrentou de perto os desafios da agricultura. Hoje, à frente do grupo Wildfarmed, promove boas práticas no setor e chegou a participar da série Clarkson’s Farm, do apresentador Jeremy Clarkson, para dar visibilidade ao projeto.



Com apoio financeiro da Clara Lionel Foundation, criada pela cantora Rihanna para impulsionar iniciativas de enfrentamento às mudanças climáticas, uma empresa de investimentos do Quênia vem fomentando o ecossistema agtech local, com foco especial em mulheres empreendedoras. Fundada em 2021, a Gather Ventures aposta em negócios em estágio inicial e oferece uma combinação de subsídios,

Assim como em outras partes da Europa, uma seca severa atingiu o sudeste da Sérvia, deixando mais de mil vacas e cavalos sem acesso à água em uma região montanhosa. Em Suva Planina, não chove desde maio, e os fazendeiros recorrem a tanques para manter os animais vivos. Alguns tentaram cavar poços, mas sem sucesso. Diante da emergência, o governo local passou a enviar caminhões-pipa para suprir a demanda. A breve chuva registrada em julho e agosto
capital de risco, empréstimos e capital de giro para viabilizar novos projetos. Até agora, a maioria das empresas apoiadas atua no setor agrícola, mas há planos de expansão para áreas como tecnologia e construção civil –segmentos em que a presença feminina ainda é limitada. A meta é ampliar o portfólio nos próximos 18 meses e chegar a 25 startups climáticas lideradas por africanos até 2026.
pouco ajudou, já que o solo estava ressecado demais para absorver a água. Embora a situação seja mais dramática na Sérvia, países vizinhos como Bósnia, Croácia, Kosovo e Albânia também enfrentam escassez hídrica. Cientistas apontam que as mudanças climáticas intensificam a frequência e a gravidade de ondas de calor e secas no continente, aumentando a vulnerabilidade da região a problemas de saúde e incêndios florestais.
O australiano Guido van Helten, 38 anos, se tornou conhecido por transformar grandes estruturas industriais em murais monumentais que contam histórias locais por meio da arte. Ele já pintou represas na Austrália e torres de resfriamento próximas a Chernobyl, na Ucrânia. Seu novo projeto está em Minot, na Dakota do Norte, região que já foi potência agrícola, mas perdeu relevância ao longo das décadas. Utilizando silos construídos nos anos 1950 e

Van Helten e suas obras: pintura e fotografia para criar painéis monumentais
um antigo elevador de grãos, van Helten combina pintura e fotografia para criar um painel inspirado na memória coletiva. Antes de iniciar o trabalho, passou semanas ouvindo relatos de moradores, e em maio começou a ilustrar os silos com temas como propriedade da terra, ancestralidade e identidade local. A iniciativa tem custo estimado em US$ 350 milhões e já garantiu 85% do financiamento por meio de doações privadas.


Do pasto ao planeta Tecnologia e manejo sustentável reposicionam a pecuária brasileira como parte da solução climática
Empresas e líderes que fazem diferença


Empresas e líderes que fazem diferença

TECNOLOGIA VOLTADA À PRODUTIVIDADE, CIÊNCIA APLICADA AOS REBANHOS E AÇÕES DE MERCADO REPOSICIONAM O SETOR COMO PROTAGONISTA DA TRANSIÇÃO PARA UMA PRODUÇÃO DE ALIMENTOS MAIS SUSTENTÁVEL
Por Lucas Bresser
Reportagem de Capa
Por muito tempo, a pecuária figurou no centro do debate climático como uma das principais vilãs responsáveis pelas emissões de gases de efeito estufa (GEE). O metano entérico emitido pelos ruminantes, o desmatamento associado à abertura de áreas de pastagens e a baixa eficiência de parte dos sistemas produtivos consolidaram uma narrativa de alto impacto ambiental. No entanto, uma nova visão vem ganhando força: a de que a pecuária, com avanços tecnológicos e práticas de manejo integradas, pode ser parte da solução climática.
Estudos recentes publicados por instituições de referência reforçam esse caminho. Uma das pesquisas, conduzida pela Empresa Brasileira de Pesquisa Agropecuária (Embrapa) no Mato Grosso, mostrou que a atividade pecuária que utiliza sistemas de Integração Lavoura-Pecuária-Floresta (ILPF), em diferentes combinações, apresenta balanço positivo nas emissões de gases de efeito estufa (GEE) no bioma Amazônia.
O levantamento, conduzido no maior experimento de ILPF do País, localizado na Embrapa Agrossilvipastoril (MT), comparou dados de quatro sistemas distintos: pastagem solteira, Integração Lavoura-Pecuária (ILP), Integração Pecuária-Floresta (IPF) e ILPF. Após quatro anos, todos os sistemas apresentaram saldo líquido negativo de carbono equivalente, ou seja, sequestraram mais carbono do que emitiram. O maior balanço foi observado no sistema IPF, com 51,3 toneladas de CO₂ equivalente por hectare (t/ CO₂eq/ha), seguido pela ILPF, com 39,5 t/CO₂eq/ ha. A ILP registrou 18,8 t/CO₂eq/ha, enquanto a pecuária convencional também conseguiu sequestrar mais carbono do que emitiu, com 26,8 t/CO₂eq/ha ao longo do período.
Ganhos em eficiência nutricional e genética poderiam reduzir em até 30% as emissões de metano entérico nos próximos anos
Em relatório de 2023, a Organização das Nações Unidas para a Alimentação e a Agricultura (FAO) destacou que ganhos em eficiência nutricional e genética poderiam reduzir em até 30% as emissões globais de metano entérico até 2050, sem necessidade de reduzir o rebanho mundial. Essas constatações mudam o foco do debate: não se trata de extinguir a pecuária, mas de transformá-la. E a mudança é urgente, especialmente considerando que, segundo estimativas da ONU, a população mundial deverá atingir quase 10 bilhões de pessoas em 2050 (atualmente, somos 8 bilhões). A própria FAO projeta que, nos próximos 25 anos, a produção global de alimentos terá de crescer 50%.
Diante do desafio de alimentar a todos sem esgotar os recursos do planeta, é preciso investir em produtividade sustentável. O Brasil, maior exportador de carne bovina do mundo e segundo maior produtor, ocupa posição estratégica nesse processo. Com um rebanho de cerca de 235 milhões de cabeças, espalhado em 160 milhões de hectares de pastagens, o País reúne tanto desafios quanto oportunidades para liderar uma pecuária de baixo carbono. “A eficiência no uso de recursos leva ao aumento da produção e da produtividade, e esse é o principal impulsionador da sustentabilidade na pecuária”, diz Nelson Ananias, coordenador de Sustentabilidade da Confederação da Agricultura e Pecuária do Brasil (CNA). “Se fôssemos produzir com os mesmos níveis de 25 anos atrás, hoje teríamos que ocupar uma área muito maior do que ocupamos de fato.” Ainda segundo o especialista da CNA, desde 2001, pouco mais de 50 milhões de hectares de pastagens deixaram de ser ocupados pela pecuária e passaram a se regenerar.

Reportagem de Capa

Marta Giannichi, da Minerva Foods: "A colaboração entre produtores e a comunidade científica é fundamental"
Se vistas apenas como área degradada, as pastagens brasileiras podem parecer parte do problema. No entanto, quando bem manejadas, tornam-se aliadas poderosas na mitigação climática. A Embrapa estima que a recuperação de 30 milhões de hectares de pastagens degradadas poderia sequestrar até 1 bilhão de toneladas de CO₂ equivalente em 20 anos. Programas como o Plano ABC+ (Agricultura de Baixa Emissão de Carbono), lançado pelo governo federal, têm justamente essa meta: incentivar a recuperação de pastagens, o uso de sistemas integrados e a fixação biológica de nitrogênio. A meta até 2030 é alcançar 72 milhões de hectares de práticas sustentáveis, com potencial de mitigar 1,1 bilhão de toneladas de CO₂e.
Grandes empresas privadas já atuam nessa frente. O Grupo Roncador, no Mato Grosso, tornou-se referência ao adotar intensificação de pastagens e integração lavoura-pecuária-floresta em larga escala, reduzindo a pressão sobre novas
Segundo levantamento da Embrapa, mais de 20 milhões de hectares no Brasil operam sob sistemas que conciliam carne, grãos e madeira na mesma área
áreas e aumentando a lotação animal por hectare. O modelo permitiu ampliar a produção sem expandir a fronteira agrícola. A integração de sistemas é um pilar da pecuária de baixo carbono. Segundo a Embrapa, mais de 20 milhões de hectares no Brasil já operam sob sistemas ILPF, que conciliam carne, grãos e madeira na mesma área. Esse modelo promove maior sequestro de carbono, melhora a fertilidade do solo e diversifica a renda do produtor.
E não é só a partir do pasto ou da integração com biomas locais que os ganhos são observados. O melhoramento genético e o manejo reprodutivo são ferramentas estratégicas para reduzir as emissões de carbono na pecuária. Por meio da seleção de animais mais eficientes – que crescem mais rápido, convertem melhor os alimentos em peso corporal e produzem mais leite por vaca –, é possível produzir a mesma quantidade de carne ou leite com menos emissões de metano entérico por quilo de produto.
Paralelamente, o manejo reprodutivo otimiza ciclos de nascimento, desmame precoce e intervalo entre partos, aumentando a produtividade do rebanho e reduzindo o tempo que cada animal permanece em pastagem ou confinamento. Assim, reduz-se a emissão acumulada de gases de efeito estufa ao longo da vida do animal. Estudos da FAO em países como o Uruguai indicam que a combinação dessas estratégias pode reduzir entre 19 e 60% a intensidade de emissões por quilo de carne produzida, ao mesmo tempo que aumenta a eficiência econômica e produtiva do setor. Um levantamento da Associação Brasileira de Inseminação Artificial (Asbia) mostra que, em 2023, foram vendidas 25 milhões de doses de sêmen bovino, um salto de 180% em relação a dez anos atrás, indicando a difusão da genética como ferramenta de eficiência.
As melhorias nutricionais também têm papel importante nesse contexto. Ao oferecer dietas balanceadas, com níveis adequados de proteína, energia e aditivos específicos, é possível aumentar a eficiência digestiva e reduzir a produção de metano por quilo de

alimento consumido. Tecnologias de nutrição de precisão, como suplementação estratégica, inclusão de leguminosas nas pastagens e aditivos redutores de metano, permitem que os animais convertam melhor os nutrientes em ganho de peso ou produção de leite, diminuindo o tempo necessário para atingir o peso de abate ou a produção desejada.
“Modular a fermentação e a digestão dos alimentos no trato digestivo dos bovinos resulta em melhor desempenho na produção de carne e leite”, afirma Ary Rodrigues Jr., CEO da Axia Agro, uma das maiores empresas de insumos agropecuários do Brasil. “Para isso, utilizamos aditivos nutricionais capazes de atuar nesse processo, evitando que microrganismos produzam metano.” O executivo explica que a rota de formação do metano no trato digestivo dos animais pode ser reduzida quando são empregadas moléculas que selecionam bactérias produtoras de ácidos graxos de cadeia curta (AGCC).
Esses AGCC são fundamentais para o fornecimento de energia, favorecendo o crescimento, a engorda e a produção de leite dos animais. “Fortes investimentos em pesquisa têm possibilitado o desenvolvimento de suplementos nutricionais inovadores para promover eficiência e sustentabilidade nos sistemas de produção animal”, diz Rodrigues Jr.
Num mercado cada vez mais sofisticado, as opções para esse tipo de produto também se multiplicam. Um levantamento da empresa DSM-Firmenich demonstrou que o uso do aditivo Bovaer pode ajudar a reduzir as emissões entéricas em até 30%. A empresa firmou parcerias com grupos como Marfrig e JBS para testar e escalar a aplicação em diferentes sistemas produtivos. “O efeito é quase imediato: em até 30 minutos, as emissões de metano são reduzidas, e nenhuma mudança nas práticas das fazendas é necessária”, diz a empresa. “O Bovaer já foi implementado com sucesso por centenas de
Reportagem

produtores na Europa, Estados Unidos, América Latina e Austrália, e já evitou, até o momento, emissões de metano equivalentes a 400 mil toneladas de CO₂e.”
A JBS, maior produtora de proteína animal do mundo, afirma que tem trabalhado para mensurar e apoiar essa transição no campo. O chamado Programa Escritórios Verdes – Fazenda Nota 10 já está presente em mais de 800 propriedades rurais em diferentes regiões do Brasil, oferecendo treinamentos, diagnósticos de emissões e definição de metas de melhoria contínua. Segundo a empresa, um estudo recente conduzido pela Fundação Getulio Vargas (FGV), pelo Instituto Inttegra e pela Fauna Projetos em 103
fazendas participantes mostrou que 31% já capturam mais carbono do que emitem.
Esse resultado está associado a práticas comprovadas, como recuperação de pastagens, manejo eficiente, dieta balanceada dos rebanhos e desmatamento zero. “A ciência é peça-chave nesse processo. Programas como o Fazenda Nota 10 só existem porque há método, análise e acompanhamento”, afirma Liège Correia, diretora de Sustentabilidade da JBS. “Com ciência, conseguimos transformar boas práticas em referências para o setor. Ampliar a colaboração entre produtores e pesquisadores, por meio de redes técnicas, benchmarks e protocolos compartilhados, é essencial para dar escala às soluções.”

Na visão da JBS, é necessário investir em toda a cadeia para garantir que produtores tenham acesso a novas tecnologias e à assistência técnica baseada em soluções naturais e escaláveis. Para a diretora de Sustentabilidade da empresa, o Brasil hoje é uma “vitrine” de soluções, com agricultura regenerativa, sistemas agroflorestais, ILP e ILPF. Além disso, o País é referência internacional em recuperação de pastagens degradadas, fixação biológica de nitrogênio, manejo racional de pasto, genética tropical voltada para eficiência alimentar e uso de aditivos nutricionais que reduzem o metano entérico. “O próximo passo é escalar essas iniciativas e consolidar nossa posição como potência agroambiental. A COP30 será uma oportunidade para mostrar, com dados e resultados concretos, que a pecuária brasileira pode ser parte da solução climática, e que o Brasil tem condições de liderar essa agenda”, diz Liège.
A Minerva Foods, outra gigante do setor no Brasil, criou o programa Renove, que promove o
engajamento de pecuaristas na adoção de práticas de baixa emissão de carbono. A iniciativa inclui visitas técnicas e a mensuração da pegada de carbono em fazendas, por meio de metodologias reconhecidas e certificação independente, assegurando rigor e credibilidade ao processo. Além disso, a MyCarbon, subsidiária da Minerva Foods, oferece soluções voltadas à agropecuária regenerativa e geração de créditos de carbono, contribuindo para a transição do setor. “Essas ações são mensuradas com base em metodologias científicas, alinhadas às melhores práticas internacionais, e têm permitido à Minerva Foods reduzir emissões e consolidar sua posição como referência em sustentabilidade”, diz Marta Giannichi, diretora global de Sustentabilidade da Minerva Foods.
A rastreabilidade e o uso de dados digitais estão se consolidando como exigência de mercado. A União Europeia aprovou regulamentação que restringe a importação de carne

AA empresa ainda atua com parceiros estratégi cos para ampliar o acesso à tecnologia. Ao lado da The Nature Conservancy (TNC), com recursos do Bezos Earth Fund, a JBS doou 2 milhões de tags para rastrear rebanhos no Pará, priorizando pequenos produtores. Já a Marfrig lançou o programa Marfrig Verde+, que integra blockchain e georreferenciamento para garantir rastreabilidade total. A Minerva, por sua vez, mantém a plataforma SMGeo Prospec, utilizada para monitorar 100% de seus fornecedores diretos na América do Sul. O mesmo aplicativo é oferecido pela companhia aos
reduziram significativamente a pegada de carbono das cadeias. Em 2023, a BRF – conhecida pelas marcas Sadia e Perdigão, hoje unida à Marfrig – reportou uma redução de 21% nas emissões quando comparadas a 2019, motivada majoritariamente pela priorização do consumo de energia renovável.
O setor também faz questão de medir ganhos e avaliar necessidades para definir para onde devem ir os investimentos. A Aurora Coop, uma das maiores cooperativas de produtores de suínos e aves do Brasil, realiza anualmente o

genético e nutricional dos animais, o manejo adequado, a ambiência, o transporte eficiente e a assistência técnica contribuem para aumentar a produtividade e reduzir a pegada de carbono”, diz Luciana Breda, coordenadora de Sustentabilidade da Aurora Coop.
Segundo os especialistas ouvidos por PLANT PROJECT, um dos desafios do setor é fazer com que as ferramentas de gestão e monitoramento cheguem a todos os pontos da cadeia de produção. Para que isso aconteça, os ganhos também têm de estar focados no aspecto econômico.
A JBS afirma que terá 100% dos fornecedores monitorados até 2025, cobrindo também os indiretos

"Temos que mostrar aos pecuaristas as boas ferramentas de gestão e monitoramento"
O desafio, em muitos casos, é justamente a viabilidade econômica da aderência às exigências internacionais. “Algumas das solicitações realizadas por mercados externos envolvem padrões e tecnologias que, embora eficazes em determinados contextos, podem se tornar economicamente inviáveis no cenário nacional, comprometendo a sustentabilidade das atividades produtivas ao longo do tempo”, diz Luciana Breda, da Aurora Coop. “A adaptação às demanMaurício Nogueira, da Athenagro:
“Temos que mostrar ao pecuarista que essas ferramentas trazem benefícios gerenciais e administrativos nas propriedades, indo além das exigências ambientais”, afirma Maurício Nogueira, da consultoria Athenagro. “No caso da rastreabilidade, os sistemas também ajudam a saber o que dá mais resultado, o que é mais viável economicamente, o que é melhor comprar e pelo que o produtor deve pagar menos ou mais.”
Reportagem de Capa
das internacionais e à realidade nacional exige dedicação e persistência, próprias do produtor brasileiro, mas também exige tempo e recursos financeiros a serem investidos que precisam ser viabilizados economicamente.”
As mudanças climáticas não pressionam apenas governos e produtores, chegando também a investidores e consumidores. O avanço das finanças sustentáveis tem colocado a pecuária sob escrutínio. Fundos internacionais condicionam aportes a compromissos ESG robustos, enquanto grandes redes varejistas globais exigem cadeias livres de desmatamento.
Nesse sentido, iniciativas de certificação vêm ganhando espaço. Programas como o Carne Carbono Neutro e o Carne Baixo Carbono, da Embrapa, certificam sistemas de produção capazes de neutralizar ou reduzir drasticamente a pegada climática da carne bovina. Produtores participantes já relatam diferenciação comercial, inclusive com prêmios de preço em alguns mercados.
Apesar dos avanços, o caminho ainda é desafiador. Segundo a FAO, o setor pecuário global responde por cerca de 14,5% das emissões de GEE – reduzir esse impacto exige ação coordenada entre ciência, política e mercado. Os especialistas apontam que é preciso ampliar investimentos em pesquisa aplicada, garantir políticas públicas de incentivo à adoção de tecnologias e melhorar a comunicação com a sociedade. “Investimentos em genética, manejo e nutrição avançada são fundamentais para aumentar a produtividade com rentabilidade e menor impacto ambiental, resultando em ciclos mais rápidos e eficientes”, resume Ary Rodrigues Jr., da Axia Agro.
O consenso é que eficiência produtiva é sinônimo de sustentabilidade. Um bovino que chega ao peso de abate em 24 meses, em vez de 36, emite significativamente menos metano ao longo da vida. Uma vaca de leite mais produtiva dilui sua emissão por litro produzido. E um sistema que recupera pastagens e integra florestas sequestra carbono e reduz pressão por abertura de novas áreas. Agora, é necessário dar cada vez mais escala à pecuária sustentável. “Da porteira para dentro, a agenda climática exige que a pecuária seja cada vez mais transparente, que cumpra os compromissos que foram assumidos pelas partes e, particularmente, pelo Brasil”, diz Nelson Ananias, da CNA. “Mas é preciso que as soluções contemplem não só a ponta, os grandes abatedouros e distribuidores, mas também os pequenos e médios produtores.”
Ao reposicionar a pecuária como parte da solução climática, o agro brasileiro assume protagonismo na oferta global de alimentos e na agenda ambiental. O desafio está em ampliar escala, difundir práticas comprovadas, integrar cadeias e garantir transparência. Para isso, é essencial trabalhar lado a lado com a ciência e o desenvolvimento tecnológico. “A colaboração entre produtores e a comunidade científica é fundamental para impulsionar a transformação da pecuária em direção a modelos mais sustentáveis”, diz Marta Giannichi, da Minerva Foods. Se o Brasil conseguir conciliar sua vocação pecuária com inovação e responsabilidade socioambiental, terá ao mesmo tempo um diferencial competitivo e uma poderosa história a contar: a de que a carne produzida no País pode alimentar o mundo enquanto ajuda a combater a mudança do clima.


• Apoio à implementação do Plano ABC+ por meio de oficinas e consultorias para os Grupos Gestores Estaduais (GGEs) de estados da Amazônia Legal.
• Organização de eventos para fortalecer a governança e a articulação institucional, além da promoção de diálogos sobre o aprimoramento da transparência e da sustentabilidade no território.
• Realização de diagnósticos no território Madeira-Mamoré para direcionar as ações do projeto e seminários sobre pecuária sustentável.

Recuperação de áreas degradadas e adoção de práticas sustentáveis de produção
Implementado pela Deutsche Gesellschaft für Internationale Zusammenarbeit (GIZ) GmbH, em parceria como o Ministério da Agricultura e Pecuária (MAPA), o projeto Transparência e Sustentabilidade em Cadeias Produtivas na Amazônia (ProTS) é uma ação estratégica que visa apoiar produtores e produtoras rurais na recuperação de áreas degradadas e adoção de práticas sustentáveis de produção.
Atuação multi-nível para o desenvolvimento de capacidades locais
Em nível nacional, o ProTS fortalece políticas públicas para cadeias agropecuárias sustentáveis e transparentes. Na região de atuação, o território Madeira-Mamoré, em Rondônia, fortalece capacidades de produtores e produtoras, especialmente da agricultura familiar, na adoção de práticas sustentáveis de produção, como sistemas integrados e agroflorestais, com foco nas cadeias da pecuária de corte e leite.




NO PRIMEIRO EPISÓDIO DA WEBSÉRIE TOP SUSTAINABLE LIVESTOCK, A TRAJETÓRIA DO GRUPO ROVEMA MOSTRA COMO A PECUÁRIA NA AMAZÔNIA PODE UNIR EFICIÊNCIA PRODUTIVA, GERAÇÃO DE RENDA E PRESERVAÇÃO DO MEIO AMBIENTE
Por Romualdo Venâncio, de Porto Velho (RO)










Criar gado de corte na Amazônia tem sido cada vez mais desafiador, ainda que se encontre ali condições favoráveis à atividade. O advento das mudanças climáticas – e suas consequências – tornou os olhares do mundo ainda mais vigilantes sobre o bioma. A cobrança pela preservação das florestas cresceu e se ramificou pelo campo das leis, a exemplo da exigência de proteção de 80% de qualquer propriedade na região, determinada pelo Código Florestal de 2008. Produzir nos 20% restantes e garantir rentabilidade e sustentabilidade demanda mais do que eficiência. No caso da Rovema Agronegócio, empresa do Grupo Rovema, a operação pecuária – sustentada pelo tripé genética, nutrição e gestão – ganhou novo fôlego com a entrada no mercado de crédito de carbono. São 22 mil hectares de mata certificados que rendem até R$ 800 por hectare/ano, ou seja, um faturamento anual de R$ 17,6 milhões para manter a floresta em pé.
A jornada do Grupo Rovema será destaque no primeiro episódio da websérie Top Sustainable Livestock, iniciativa dedicada a demonstrar como a pecuária pode unir produtividade, rentabilidade e responsabilidade socioambiental. Por meio de exemplos concretos já aplicados no País, a série revela caminhos reais para transformar o setor em um modelo de produção sustentável, provando que preservar e prosperar podem caminhar lado a lado. Ela será veiculada no Canal Terraviva, do Grupo Bandeirantes, e é realizada por PLANT PROJECT em parceria com a Mesa Brasileira da Pecuária Sustentável, com apoio dos projetos SAFe e ProTS, implementados pela Deutsche Gesellschaft für Internationale Zusammenarbeit (GIZ) GmbH em parceria com o Ministério da Agricultura e Pecuária (Mapa), IDH Transforming Markets, MSD Saúde Animal e ApexBrasil.
O Grupo Rovema nasceu há 40 anos, com a fundação da empresa Jacto Eletro Diesel pelos
Confinamento na fazenda Serra Verde: seleção genética e dieta precisa garantem precocidade para abater 10 mil cabeças por ano

primeiros membros da família Ghedin, em alguns casos também grafado como Guidin, que chegaram a Porto Velho (RO). O objetivo era prestar serviços ao setor de garimpo, mas o progresso nas novas terras abriu espaço para a investida em outros negócios, inclusive na pecuária. O rebanho, que começou a ser formado há 25 anos, conta hoje com 10 mil cabeças da raça Nelore, das quais 3 mil são matrizes.
A atividade de ciclo completo – cria, recria e engorda – é dividida em duas propriedades. A Fazenda Rio Madeira abriga toda a parte de seleção genética. É onde se faz a cria e a recria. Já a engorda e a terminação dos animais que vão para o abate são realizadas na Fazenda Serra Verde, que abriga o confinamento. “Há seis anos, ingressamos também no negócio de grãos, plantando milho e soja. O capim (Brachiaria ruziziensis) entra como cultura intermediária, para soltar o gado”, diz o CEO do
Grupo Rovema, Adélio Barofaldi. “São três culturas com a integração lavoura-pecuária. Isso é um ciclo completo que a Amazônia permite fazer com qualidade.”
A demanda de terras para a agricultura diminuiu o espaço para a pecuária. Mas reduzir o rebanho e a produtividade não era uma opção – pelo contrário, já que os índices do gado aumentaram. “Isso é resultado de investimento, tecnologia, confinamento e da verticalização, movimento crucial para a expansão”, afirma o diretor financeiro do grupo, Gilvan Guidin. Foi nessa toada que surgiu a fábrica de ração, inicialmente para consumo do próprio gado, que foi ampliada para uma indústria de nutrição animal, a Sustennutri, atendendo também o mercado local.
Tudo é planejado e executado às minúcias, otimizando cada etapa e ganhando em tempo e qualidade, fator determinante para a produção


sustentável de carne bovina dentro do bioma amazônico. A seleção dos animais é outro ponto fundamental, em um processo que teve início em 1999, com a adoção da inseminação artificial. Em 2002, o rebanho passou a integrar o Programa de Avaliação e Identificação de Novos Touros (Paint), voltado à mensuração das características herdáveis ligadas à produção e à reprodução. O programa permite identificar e selecionar animais com maior potencial genético, favorecendo a evolução do rebanho por meio de maior pressão de seleção, redução do intervalo entre gerações e, consequentemente, maior retorno econômico. A partir dessa avaliação, os touros recebem o Certificado Especial de Identificação e Produção, o Ceip, que funciona como um selo de qualidade.
Naquele mesmo ano, a Rovema Agronegócio se tornou sócia da Associação Brasileira de Criadores de Zebu (ABCZ), e os animais destinados à reprodução – touros e matrizes –passaram a ter o registro da entidade, uma
chancela para os padrões raciais do rebanho. Mais do que isso, é uma credencial para a participação em grandes leilões e a ampliação do alcance do trabalho desenvolvido em Porto Velho, atendendo outros rebanhos. Dessa forma, o melhoramento genético não fica restrito às propriedades do grupo, mas acaba aprimorando os rebanhos da região, gerando uma positiva reação em cadeia.
Esse modelo de gestão também tem se traduzido em avanços de sustentabilidade. A pressão de seleção genética, associada a uma dieta balanceada e precisa, permite o desmame de bezerros mais pesados, o que se reflete na maior precocidade dos animais e em ganhos expressivos no peso final de abate. “Hoje, o boi sai da fazenda para o frigorífico com 20 a 23 meses. No passado, demorava 48 meses, ou seja, quatro anos. Estamos economizando dois anos de pasto”, diz Barofaldi.
Os índices tendem a melhorar ainda mais, já que a idade de desmame vem sendo reduzi-
No meio da mata: em pé, Adélio B arofaldi, C arolina B razil, Valdecir G uedin e G ilvan G uidin; agachada, L ediana L opes

da de oito para cinco meses, o que é resultado da adoção de um novo manejo de bezerros.
“Eles saem do pé da mãe e vão para um piquete separado no confinamento, onde começam a receber uma suplementação leve e a ganhar carcaça”, afirma o diretor de Agronegócio, Valdecir Luiz Ghedin. “Tenho a convicção de que poderemos abater o gado com até 19 meses.” Além de todo o ganho durante o ciclo de produção, ainda há o impacto no produto final. “A carne que levamos ao mercado é bem mais saborosa”, diz o médico veterinário Rodrigo Junqueira, responsável pelo rebanho.
Embora essas estratégias e ferramentas de manejo já colocassem o rebanho da Rovema em posição de destaque no campo da sustentabilidade, ainda havia espaço para avançar. Novas possibilidades surgiram a partir da inspiração no conceito de “ambientalmente correto” aplicado em outra frente de atuação do grupo. Com o objetivo de ampliar as operações da Rovema Bank (antiga UzziPay), fintech do conglomerado,
nasceu a iniciativa de preservar uma árvore a cada nova conta aberta. Para dar consistência ao projeto e comunicar de forma mais clara seu propósito, a empresa contou com o apoio de uma consultoria especializada na definição da estratégia. “Separamos uma área da fazenda e mostramos que esse espaço seria dedicado exclusivamente à preservação, e foi aí que a consultoria nos surpreendeu”, diz a diretora institucional do Grupo Rovema, Lediana Ghedin Lopes. “Disseram que estávamos perdendo a oportunidade de utilizar o crédito de carbono daquela área em prol de um bem maior dentro das estruturas das fazendas.”
O alerta caiu como uma provocação, e a diretoria do grupo se apressou em saber mais sobre o assunto e entender como poderia ingressar no mercado de crédito de carbono. Naquele momento, entre o final de 2021 e o início de 2022, surge também a figura do desenvolvedor, a empresa responsável por elaborar o projeto, trazendo mais esclarecimentos. Esse processo é


longo e complexo. Até chegar à maturação, quando vem o retorno financeiro, há muitas etapas – preparação, certificação, homologação – que representam um custo muito alto, e às vezes até impeditivo. A solução para torná-lo acessível foi buscar parceiros.
O Grupo Leite e o Grupo Tupá uniram-se à Rovema para reduzir a emissão de dióxido de carbono e conter o desmatamento nas regiões de Porto Velho (RO) e Lábrea (AM). Dessa parceria nasceu o Projeto Rio Madeira REDD+ (Redução de Emissões por Desmatamento e Degradação Florestal) Agrupado, desenvolvido pela Future Climate e integralmente formado por áreas de floresta amazônica. “É um processo burocrático, mas altamente rentável”, afirma Barofaldi. “Estando na Amazônia, preservar já é uma obrigação. Com o projeto de créditos de carbono, porém, conseguimos atribuir muito mais valor à
floresta em pé do que deitada.”
Pelo posicionamento geográfico das fazendas da Rovema Agronegócio, o potencial de geração de créditos de carbono é ainda maior, já que a região apresenta alto nível de supressão florestal. Trata-se de uma área historicamente marcada pelo desmatamento, onde a pressão pela derrubada de árvores permanece intensa. Enfrentar essa realidade exige o engajamento não apenas da empresa, mas também de produtores vizinhos e da comunidade local. Por isso, a Rovema investe na disseminação desse conceito, promovendo informação e conscientização sobre o valor da preservação. “Acabamos sendo um espelho para toda a sociedade”, afirma Gilvan Guidin. Para Barofaldi, o trabalho de conscientização é ainda mais valioso porque a ideia não é tão clara. “O crédito de carbono ainda é uma
Ao lado, Barofaldi, que se diz o "mascateiro do crédito de carbono na Amazônia"; abaixo, matrizes nelore de alto padrão genético

expressão que gera muita desconfiança, pois há poucos projetos aprovados, que estão viáveis comercialmente”, diz o CEO do Grupo Rovema. O executivo aproveita sua posição de liderança no agronegócio rondoniense para multiplicar essa concepção: “Temos feito um trabalho de divulgação muito forte, estamos promovendo reuniões sobre o tema. Eu me tornei o ‘mascateiro’ do crédito de carbono”. Segundo o executivo, ainda há obstáculos que limitam a expansão do conceito e a adesão de mais propriedades ao mercado de crédito de carbono. Para superá-los, é necessário avançar na normatização, criar regras mais claras, ampliar os mecanismos de comercialização e, sobretudo, dar maior atenção à regulação fundiária, já que uma das principais dificuldades de Rondônia é a regularização de terras que ainda carecem de documentação. “No
entanto, é certo que o crédito de carbono vai se tornar, a médio e longo prazos, importante receita também para pequenos produtores, que precisam ter remuneração para manter a floresta em pé”, diz Barofaldi.
A confiança do Grupo Rovema na pecuária sustentável e na progressão desse modelo é tamanha que o projeto foi estruturado para atravessar gerações. O contrato inicial do Projeto Rio Madeira REDD+ Agrupado prevê 30 anos de duração, mas, ao longo do processo e das auditorias periódicas, foi firmado um termo de compromisso que estende a preservação da floresta por mais 100 anos. Na prática, trata-se do cultivo de um futuro mais sustentável. “É uma forma de perpetuar a melhoria da qualidade de vida das pessoas e de garantir equilíbrio econômico e social no entorno do projeto”, conclui Lediana.



INICIATIVA BRASILEIRA BUSCA CAPTAR US$ 125 BILHÕES PARA TRANSFORMAR A CONSERVAÇÃO DAS FLORESTAS TROPICAIS EM ATIVO ECONÔMICO ESTRATÉGICO




Apreservação das florestas tropicais deixou de ser apenas uma pauta ambiental para se tornar questão central na economia global. A crescente pressão internacional sobre os países que abrigam grandes áreas verdes, como o Brasil, vem acompanhada da necessidade de criar mecanismos que deem valor econômico à conservação. É nesse cenário que surge o Fundo Florestas Tropicais para Sempre (Tropical Forest Forever Facility – TFFF), proposta brasileira que busca transformar a maneira como se financia a proteção ambiental no mundo.
Apresentado na COP28, em Dubai, em 2023, e com lançamento oficial previsto para a COP30, em Belém, no Pará, em 2025, o fundo busca captar até US$ 125 bilhões para garantir pagamentos permanentes aos países que mantêm suas florestas em pé. O modelo tem despertado atenção não apenas de governos e organismos multilaterais, mas também do setor privado, por meio de bancos, fundos de investimento e grandes corporações que já se movimentam para participar.
“Manter as florestas tropicais em pé é algo absolutamente estratégico”, diz o físico Paulo Artaxo, professor da Universidade de São Paulo (USP) e especialista na dinâmica climática da Amazônia. “A Amazônia, por exemplo, armazena cerca de 120 bilhões de toneladas de carbono, o equivalente a dez anos de toda a queima de combustíveis fósseis do planeta.” Segundo Artaxo, se todo esse carbono fosse liberado na atmosfera, os cenários de mudanças climáticas globais se agravariam significativamente.
A proposta brasileira rompe com o modelo tradicional de doações internacionais. O TFFF foi desenhado como um fundo de investimento global, no qual 20% do capital virá de aportes públicos (governos e instituições multilaterais) e 80% do mercado financeiro, por meio da emissão de títulos de dívida com rendimento competitivo. O retorno aos investidores será garantido pela carteira diversificada do fundo. Uma parte do lucro remunera quem colocou o dinheiro, enquanto o excedente financia os pagamentos anuais aos países tropicais que conseguirem preservar suas áreas de floresta. O cálculo é direto: cerca de US$ 4 por hectare protegido a cada ano.
“O TFFF é um mecanismo robusto e inovador de investimento público e privado, que direciona recursos diretamente para quem conserva as florestas”, afirmou a ministra do Meio Ambiente, Marina Silva, durante a Semana de Ação Climática de Londres, em junho. “À medida que nos aproximamos da COP30, precisamos da ousadia para criar um novo pacto entre clima e floresta, ajudando a estabelecer um ciclo de prosperidade, com coragem e capacidade disruptiva para mudar, antes que sejamos abruptamente mudados pelas adversidades climáticas.”
Ararajuba, ave encontrada em área do projeto "Monitoramento da Biodiversidade", da Agropalma: iniciativa contribuiu para o registro de novas espécies na amazônia
Para evitar distorções, o fundo também prevê penalidades pesadas no caso de descumprimento dos acordos. Cada hectare desmatado pode custar entre US$ 400 e US$ 800 em multas, além de US$ 100 para cada hectare degradado. Ou seja, o incentivo é positivo (pagar por conservar), mas também punitivo para quem destruir. Outro ponto relevante é que 20% dos recursos pagos aos países deverão ser obrigatoriamente destinados a povos indígenas e comunidades tradicionais, reconhecendo o papel estratégico desses grupos na proteção das florestas.
Um dos diferenciais do TFFF é a simplicidade metodológica. Os critérios de elegibilidade exigem que os países mantenham baixas taxas de desmatamento (até 0,5% ao ano). O monitoramento será feito por meio de imagens de satélite, padronizadas e auditadas internacionalmente, com os dados abertos ao público. Essa abordagem evita burocracias associadas a cálculos de estoques de carbono e
facilita a checagem independentemente dos resultados. “É um caminho para colocar valor na natureza sem transformá-la em uma commodity”, diz a cientista política, ambientalista e ex-ministra do Meio Ambiente da Colômbia Susana Muhamad. Para Artaxo, o avanço tecnológico favorece a metodologia proposta para o TFFF. “Hoje, a ciência tem ferramentas extremamente efetivas, com a utilização de sensoreamento remoto, para mapear não só a extensão, mas também a saúde das florestas tropicais. E o Brasil tem liderança mundial nesses sistemas”, diz o cientista.
Se alcançar a meta de captação, o TFFF poderá canalizar bilhões de dólares por ano para países detentores de florestas tropicais, entre eles Brasil, Colômbia, Indonésia, República Democrática do Congo e Gana. A expectativa é de que a iniciativa contribua para reduzir emissões de carbono e ajudar na meta de limitar o aquecimento global a 1,5 °C, além de fortalecer a bioeconomia

A expectativa é de que, a partir de Belém, o mundo veja nascer um modelo permanente de financiamento para florestas tropiciais
nas regiões rurais, gerando renda com base em produtos e serviços ambientais. Outro benefício é que o TFFF poderá oferecer mais segurança financeira a países e comunidades que hoje dependem de recursos escassos e pontuais. O TFFF não substitui iniciativas já existentes, como os mercados voluntários de carbono ou o REDD+, mas se soma a elas, criando uma camada adicional de previsibilidade e escala. “Normalmente, o REDD+ financia áreas sob alto risco de desmatamento, enquanto regiões historicamente bem preservadas acabam recebendo pouco apoio”, afirma Thaise Emilio, professora do Instituto de Biociências da Universidade Estadual Paulista (Unesp) e pesquisadora do Centro de Pesquisa em Biodiversidade e Mudanças do Clima (CBioClima). “O TFFF pode valorizar e proteger também esses territórios, reconhecendo sua importância para manter serviços ecossistêmicos vitais.”
O fundo tem recebido endossos de países como Alemanha, Reino Unido, Noruega, Colômbia, Emirados Árabes Unidos e Malásia. Além disso, no início de julho, durante a cúpula do Brics, a China anunciou que deverá injetar recursos no projeto. Organismos multilaterais como Banco Mundial, OCDE e PNUD estão envolvidos na modelagem da governança. Entidades ambientais como WWF, Conservation International e Wildlife Conservation Society também colaboram. Essa convergência aumenta a chance de o TFFF se consolidar como novo paradigma do financiamento climático global. Outro respaldo político importante ao TFFF vem dos nove países sul-americanos abrangidos pela Amazônia. Em agosto, Brasil, Peru, Colômbia, Bolívia, Equador, Venezuela, Guiana, Guiana Francesa e Suriname divulgaram comunicado oficial manifestando apoio à criação do mecanismo.


Um dos aspectos mais inovadores é a forma como o TFFF atrai o capital privado. Bancos e fundos de investimento internacionais como Pimco, Barclays e Bank of America já sinalizaram interesse em participar. Para as empresas, inclusive do agronegócio, trata-se de uma oportunidade dupla: contribuir para a preservação das florestas tropicais e alinhar suas cadeias de valor às exigências ambientais globais. O Brasil, como maior detentor de florestas tropicais do planeta, tem papel estratégico e responsabilidades nessa equação.
Um exemplo concreto desse movimento vem da Agropalma, maior produtora de óleo de palma do País e reconhecida mundialmente como referência em sustentabilidade. Instalada há mais de 40 anos na Amazônia, a companhia mantém em Tailândia (PA) 107 mil hectares, dos quais 64 mil são reservas florestais preservadas. Desde 2002, a empresa adota uma política rigorosa de desmatamento zero, investindo aproximadamente R$ 2 milhões por ano em proteção das florestas e da biodiversidade. A estratégia envolve equipes permanentes de guardas florestais, sistemas de
monitoramento por câmeras e ações de prevenção contra a exploração ilegal de madeira.
O compromisso vai além da vigilância. Em parceria com a Conservation International, a Agropalma monitora mais de mil espécies da fauna amazônica – muitas endêmicas e ameaçadas de extinção, como a ararajuba, o macaco cuxiú-preto e a onça-pintada. O trabalho inclui 18 trilhas de observação da biodiversidade e já contribuiu para o registro de novas espécies na região. A companhia também apoia o PPBio-AmOr, programa de pesquisa em biodiversidade coordenado pela UFPA e pela Universidade de Bristol, viabilizando expedições científicas em suas áreas de reserva legal.
Para Túlio Dias Brito, diretor de Sustentabilidade da Agropalma, iniciativas como essas mostram que desenvolvimento econômico e a proteção ambiental podem andar juntos: “É motivo de orgulho sermos uma empresa com desmatamento zero, que monitora continuamente a biodiversidade com padrões de excelência. A conservação gera benefícios para toda a socieda-
A COP30 , em Belém, poderá resultar na criação de um pacto entre clima e floresta, ajudando a estabelecer um ciclo de prosperidade

de, como estabilidade climática, preservação da biodiversidade e avanço científico”.
O lançamento oficial do Fundo está previsto para a COP30, em Belém, em novembro. Até lá, os esforços estão concentrados em estruturar juridicamente o mecanismo, captar compromissos iniciais e definir salvaguardas sociais e ambientais. A expectativa é de que, a partir de Belém, o mundo veja nascer um modelo permanente de financiamento para florestas tropicais, capaz de equilibrar os interesses de governos, investidores privados, comunidades locais e do setor produtivo.
Apesar do entusiasmo, o fundo também enfrenta desafios significativos. Um dos principais entraves passa pela relação com o Banco Mundial, instituição escolhida para estruturar e viabilizar a operação do TFFF. Como os Estados Unidos detêm mais de 30% do poder de voto no banco, as recentes tensões diplomáticas entre Brasília e Washington podem impactar o ritmo de implementação do mecanismo. “O Banco Mundial é parceiro fundamental desde o início e agrega muita confiança dos investidores, mas agora é
uma questão política dentro da instituição”, disse André Aquino, assessor especial do Ministério do Meio Ambiente, durante evento do Imaflora.
Segundo Aquino, o governo brasileiro já avalia alternativas junto a outros bancos multilaterais, mas reconhece que nenhum teria o mesmo peso simbólico e técnico do Banco Mundial.
O Fundo Florestas Tropicais para Sempre carrega o simbolismo de ter sido concebido no Brasil, país que abriga a maior floresta tropical do planeta e cujo agronegócio depende diretamente dos serviços ecossistêmicos que ela proporciona. A iniciativa não resolve sozinha os dilemas do desmatamento e das pressões econômicas sobre a floresta, mas oferece um caminho inovador para monetizar a conservação de forma contínua, previsível e escalável. “Não se trata de mercantilizar a natureza, mas de reconhecer, de forma concreta, o valor que ela tem para a sobrevivência humana e para a economia global”, diz Susana Muhamad. Para o agronegócio, a mensagem é clara: preservar deixou de ser apenas uma responsabilidade moral. É também, cada vez mais, um bom negócio.












COM ALLFLEX® .

Sistema de identificação que atende às exigências de rastreabilidade.

Mais controle e gestão na sua fazenda.



Identificadores Allflex® Qualidade que se vê de longe.












Por Ronaldo Luiz

No agronegócio, cada vez mais competitivo e de margens apertadas, pequenos e médios produtores enfrentam desafios extras para obter preços justos. A agricultura de commodities exige grande escala para ser viável, enquanto a produção de itens específicos permite maior diferenciação e geração de renda. Nesse contexto, a Identificação Geográfica (IG) surge como uma estratégia eficaz para agregar valor e abrir novos mercados. Concedido pelo Instituto Nacional da Propriedade Industrial (Inpi), o selo reconhece a origem única de um produto, atestando sua qualidade, tradição e reputação ligadas ao local de produção.
Produtos com Indicação Geográfica (IG) têm qualidade única, resultado da combinação de fatores naturais – como solo, vegetação e clima – com saberes tradicionais desenvolvidos pelas comunidades locais. Esse selo garante identidade própria, valoriza a cultura regional e estimula a economia. O queijo parmesão de Parma, na Itália, é um exemplo clássico. No Brasil, com sua diversidade de sabores e tradições, a IG se consoli-
da como uma ferramenta essencial: protege produtos típicos e pode transformar a agricultura familiar em motor econômico e cultural.
“A IG reconhece que o produto não é só aquilo que está no prato – é o território, o clima, o modo de fazer, a cultura que o cerca”, afirma a médica veterinária Paula Eloize, especialista em segurança dos alimentos. No Brasil, pelo menos 130 produtos agrícolas possuem Indicação Geográfica registrada. O número ainda é tímido quando comparado ao potencial cultural e produtivo das regiões brasileiras. “Queijos artesanais, mel, carne de raças nativas, erva-mate e cafés especiais são apenas alguns exemplos de produtos que já se beneficiam dessa certificação, com impactos diretos em renda, permanência no campo e reconhecimento internacional”, acrescenta Paula.
Segundo Junio Correia da Silva, gestor de Projetos do Sebrae, a certificação de Indicação Geográfica – que inclui as categorias Indicação de Procedência (IP) e Denominação de Origem (DO) – não só protege o nome de um produto como

também abre espaço para mercados premium, turismo rural e políticas públicas de incentivo. Ressalte-se que o reconhecimento exige critérios específicos, como a delimitação clara da região de origem, a organização dos produtores locais e a apresentação de um regulamento de uso.
A Indicação de Procedência (IP) valoriza a reputação de uma região como centro reconhecido de produção, enquanto a Denominação de Origem (DO) exige vínculo direto entre o território e as características únicas do produto, ligadas a fatores naturais e ao saber-fazer local. No Brasil, vinhos, espumantes, cafés e queijos lideram os registros de IG – o Vale dos Vinhedos foi o primeiro, em 2002 –, mas a lista inclui itens como mel de aroeira de Minas, balas de banana de Antonina (PR), erva-mate de São Matheus (PR), açafrão de Mara Rosa (GO), própolis de Alagoas, artesanato de Jaguaribe (CE), panelas de barro de Roraima, maçã de São Joaquim (SC) e guaraná de Maués (AM).
Para Marina Zimmermann, consultora técnica
No Brasil, vinhos, espumantes, cafés e queijos lideram os registros de Indicação Geográfica

Paula Eloize, especialista em Segurança de Alimentos: selo traz reconhecimeto internacional
do Instituto CNA, as Indicações Geográficas refletem tradição, cultura e qualidade, abrindo espaço em mercados especializados e aumentando a confiança do consumidor. Ao proteger produtores da concorrência desleal, garantem preços mais justos, estimulam o desenvolvimento sustentável e preservam saberes locais. O queijo canastra, em Minas Gerais, é exemplo de como a IG pode transformar a produção artesanal em ativo valorizado no Brasil e no exterior, elevando a renda das famílias e fortalecendo o turismo rural.
A Indicação Geográfica, de fato, funciona como selo de confiança, mas sua expansão no Brasil esbarra em falta de apoio técnico, burocracia e carência de capacitação, sobretudo para produtos de origem animal. “O que falta muitas vezes não é produto, mas política pública e valorização da identidade alimentar”, afirma Paula Eloize, destacando que o sucesso das IGs depende da articulação entre governos, universidades e cooperativas para transformar tradição em valor de mercado e desenvolvimento rural.
















Onde todo mundo vê um empreendedor, a ApexBrasi l vê um exportador.




















SEJA NAS PLANTAÇÕES, SEJA EM FUNÇÕES ADMINISTRATIVAS, O AGRONEGÓCIO É TERRENO IMPORTANTE PARA RECEBER PROFISSIONAIS PORTADORES DE ALGUM TIPO DE DEFICIÊNCIA
Por Mário Sérgio Venditti

Há 18 anos, Cristiano de Souza Sarmento segue a mesma rotina. Depois do café da manhã, ele se despede da esposa, Henriqueta, e toma o ônibus fretado em frente ao seu condomínio rumo à fábrica da AGCO – multinacional de equipamentos e tecnologias agrícolas –, em Canoas (RS). Ali, pontualmente às 7h30, ocupa seu lugar no núcleo de pré-montagem do filtro do motor dos tratores da Massey Ferguson e Valtra, duas das marcas da AGCO, para cumprir sua jornada de trabalho. A cena parece comum para o cotidiano de muita gente, se não fosse por uma particularidade: Sarmento é deficiente visual.
Quando o carrinho carregado de peças estaciona ao seu lado, Cris, como é chamado pelos colegas, separa os cem componentes necessários, e devidamente memorizados, para montar o filtro em aproximadamente dois minutos e meio com precisão impecável. “Confiro cada peça com o tato e, às vezes, identifico um defeito que passaria despercebido
para quem usa apenas a visão”, afirma.
Antes de ingressar na AGCO, ele trabalhou por cinco anos como office boy na Associação de Deficientes Visuais de Canoas. Mas, ao concluir o ensino médio, procurou novas oportunidades. “Sempre quis trabalhar em uma multinacional e participei de um processo seletivo da AGCO. Fui aprovado em várias etapas até ser contratado”, relembra. Ao longo de três meses, Sarmento teve a companhia de outro funcionário, que lhe ensinou todas as fases da montagem de radiadores.
Ele faz questão de ressaltar que não tem nenhum tipo de privilégio. “Sou cobrado como qualquer colaborador e sem coitadismo, porque não sou diferente de ninguém. Apenas uso outros sentidos para fazer o mesmo trabalho”, diz. Inquieto, o montador jamais permitiu que sua limitação servisse de obstáculo para evoluir na empresa. Sarmento formou-se em Logística e participa ativamente dos programas de ideias da AGCO abertos aos funcionários.
A ação é uma espécie de incubadora de
O deficente visual Cristiano Sarmento ( à esq. ), da AGCO, e Fernando dos Santos, da Jacto, que perdeu os movimentos do braço

sugestões viáveis, no sentido de trazer melhorias para a fábrica. Em 2017, uma ideia de Sarmento colocada em prática resultou em economia e otimização de tempo na linha de produção. Como prêmio, ganhou um automóvel zero-km, vendido em seguida para quitar seu apartamento onde mora com Henriqueta, que também é deficiente visual.
Sarmento faz parte da lista de 5% de pessoas PcD (portadores de alguma deficiência) do quadro de 2.500 colaboradores da AGCO no Brasil. Segundo a Lei 8.213/91, também conhecida como Lei de Cotas para Pessoas com Deficiência, as empresas com mais de 100 funcionários devem preencher de 2 a 5% das vagas de emprego com esse público. Angelica Kanashiro, vice-presidente de Recursos Humanos da AGCO América Latina, explica que o objetivo da companhia não se resume a obedecer a legislação. “Nosso propósito é incluir o candidato em todos os processos da AGCO, levando em conta suas habilidades e aspirações”, destaca.
O Instituto Brasileiro de Geografia e Estatística (IBGE) divulgou, em maio passado, que o Brasil tem 14,4 milhões de pessoas com deficiência – números colhidos no último Censo realizado no País, em 2022. Cerca de três milhões moram em domicílios rurais. Não existem, porém, informações precisas a respeito do contingente PcD envolvido diretamente na cadeia do agronegócio nacional. De toda forma, o estado de São Paulo dá algumas pistas. Dados de 2023 da Relação Anual de Informações Sociais (Rais), atrelada ao Ministério do Trabalho e Emprego, revelam que 28,5% dos profissionais do agronegócio paulista possuem algum tipo de deficiência. Boa parte deles está alocada em áreas administrativas.
É o caso de Fernando Rudnei dos Santos, 41 anos, comprador da Jacto, empresa de máquinas, soluções e serviços agrícolas. Ele perdeu os movimentos do braço esquerdo aos 22 anos, depois de bater sua motocicleta desgovernada em uma placa de trânsito, acidente que o

A OPERAÇÃO DO USUÁRIO
Aindústria de equipamentos agrícolas vem olhando com mais atenção para as necessidades do público PcD. Um exemplo é o lançamento, em 2023, do primeiro trator agrícola acessível do mundo, fabricado pela New Holland. Com projeto 100% brasileiro, o TL5 Acessível é destinado a pessoas com deficiência motora nos membros inferiores, permitindo que elas façam as atividades no campo de maneira independente. “A principal premissa da inclusão é que os portadores de alguma deficiência – as que também vivem e trabalham nas fazendas – querem ter autonomia para realizar suas atividades por conta própria”, afirma Eduardo Kerbauy, vice-presidente da New Holland para a América Latina. “O TL5 ajuda a eliminar barreiras que impossibilitam muitos agricultores de se acomodarem no posto de operação de uma máquina.”
A ideia de adaptar o TL5 nasceu a partir da demanda de produtores, que foram fundamentais para a fabricante chegar ao produto final. Produzido a partir da linha de tratores TL5, o modelo pode ser usado nas principais tarefas da propriedade rural, como preparação de solo, plantio, distribuição de calcário, colheita em pequenas fazendas, silagem, roçagem e distribuição de fertilizantes.
Ele é equipado com uma plataforma de elevação e um joystick para o operador comandar os movimentos necessários do embarque e desembarque, além dos controles adaptados do trator. A empresa também está desenvolvendo um dispositivo de telemetria, para que o usuário visualize as informações da máquina no aplicativo de gestão de frota.
Trabalhador na colheita: segundo o mais recente censo do IBGE , o Brasil tem 14,4 milhões de pessoas com deficiência

deixou sete dias em coma. Vindo de uma família humilde da cidade de Pompeia (SP), Rudnei sempre se virou para faturar uns trocados na juventude: carregava sacolas de compras das donas de casa durante o dia e à noite trabalhava em uma lanchonete.
O episódio mudou radicalmente sua vida. Ao sair do hospital, ele ficou seis meses deitado quase todo o tempo com um colar cervical para proteger a região do pescoço. Sem condições de exercer qualquer atividade, passou a depender da família. “Nos primeiros dias de recuperação, me sentia muito para baixo, desanimado. Felizmente, mudei meu pensamento e me conscientizei de que não poderia desistir de prosperar, de perseguir meus objetivos. Perdi os movimentos do braço, mas não a vida”, salienta. Recuperado, lançou-se ao mercado de trabalho. No computador de uma lan house, Rudnei soube da abertura de um programa de treinamentos promovido pela parceria Senai-Jacto, que poderia lhe garantir uma colocação
na companhia ligada ao agronegócio. Ao final do curso de dois anos, uma vaga de auxiliar de compras em Pompeia foi aberta e Rudnei a agarrou. Escalou posições na empresa, hoje ocupa o cargo de comprador e quer subir ainda mais até chegar a comprador sênior. “Sou responsável pela aquisição de um mix amplo de produtos, que vai de canetas a tratores”, diz. Durante o expediente, ele usa uma tipoia para evitar dores nas costas. “Meu braço é um peso morto”, justifica. Rudnei dirige normalmente um automóvel com câmbio automático. Moto, nunca mais. Afinal, o impacto causou uma lesão no plexo braquial, rede de nervos que se originam na região cervical e torácica e se estendem até o braço. Olhando para trás, ele acredita que o pedido indeferido de aposentadoria por invalidez foi a melhor coisa que lhe aconteceu no período pós-acidente: “Se eu estivesse aposentado, não teria crescido tanto”, acrescenta.
Segundo dados da Relação Anual de Informações Sociais (Rais), as pessoas PcD não pleiteiam

aposentadoria em primeiro lugar, mas sim oportunidades de trabalho. Elas podem contar com uma grande aliada nesse sentido. A advogada Laura Meireles, especializada em direito do agronegócio, é uma incansável batalhadora da causa dos portadores de deficiência no setor. Ela assegura que, embora a topografia dos terrenos das propriedades dificulte a movimentação de cadeirantes, as adaptações ajudam a inserir totalmente quem tem mobilidade reduzida nas atividades do agronegócio.
Oriunda de uma família produtora de gado de corte e de leite de Patos de Minas (MG), Meireles já elaborou uma série de projetos inspirados no programa Agroability, dos Estados Unidos. Eles reúnem, entre seus pilares, a inclusão de pessoas com deficiência no campo, desenvolvendo habilidades e investindo em novos dispositivos, como cadeira de rodas com pneus especiais e acesso mais facilitado às
cabines das máquinas agrícolas.
No entanto, a advogada esbarra na dificuldade de conseguir apoio. “Com a participação de sindicatos rurais e universidades, há muitas ideias personalizadas que podem ser implementadas no agronegócio, dependendo da necessidade do produtor. Os bancos entrariam com o financiamento para essas soluções com juros mais baixos”, diz. “Muitas empresas gostam do projeto, mas, em seguida, desaparecem. O governo também poderia ajudar.” Ela entende que ainda existe um olhar preconceituoso ao público PcD: “Algumas pessoas com mobilidade reduzida deixam a roça e vão para a cidade porque se acham incapazes de executar atividades no campo”.
Abandonar o campo jamais passou pela cabeça de Angelo Sarmento Klein, 34 anos. Morador da pequena cidade de Almirante Tamandaré do Sul (RS), ele dirige o trator John Deere 6210 M com desenvoltura nas plantações
A advogada especializada em direito do agro Laura Meireles e Angelo Klein, com prótese na perna: setor é cada vez mais inclusivo

de soja, trigo e aveia na fazenda da família, apesar da prótese da perna esquerda. Klein sofreu uma tragédia pessoal aos 5 anos de idade: “Estava no carro do meu tio em um passeio nas Ruínas de São Miguel das Missões, quando ele foi pegar um revólver calibre 12 dentro do porta-luvas. A arma disparou acidentalmente e atingiu minha perna”.
A partir daí, seguiu-se a corrida desesperada em busca de um hospital com mais recursos para atendê-lo. Ele foi levado para prontos-socorros nos municípios gaúchos de Santa Rosa e Santo Ângelo até chegar a Passo Fundo. Com quadro de trombose ameaçando sua saúde, a amputação acima do joelho foi a decisão urgente encontrada pelos médicos. Em seguida, não demorou para receber a prótese. “Por um lado, foi bom perder uma perna bem novo, porque daí nem lembro como era minha vida com as duas”, diz, com bom humor.
Klein cresceu na propriedade de 330 hecta-

res de área cultivada, ao lado do pai, Aristides. Hoje, no comando do trator, realiza todas as operações necessárias, como preparação do solo para o plantio, pulverização, transporte de implementos e colheita. A seu ver, as principais dificuldades no trabalho das lavouras é conseguir mão de obra qualificada e adquirir os equipamentos com tecnologias mais modernas. “O campo paga bem, mas o agro exige dedicação total do funcionário”, afirma.
Ele só se ausenta temporariamente de suas raízes quando precisa ir para a capital, Porto Alegre, a 311 km de Almirante Tamandaré do Sul, fazer a manutenção da prótese, que tem o mecanismo do joelho eletrônico, o pé confeccionado em fibra de carbono e algumas partes de titânio. Mas não demora a regressar. Afinal, é no seu refúgio, uma cidadezinha de 2 mil habitantes, que ele guarda seus maiores tesouros: o contato com o campo e o filho, Adriano, de nove meses.
Com tecnologia exclusiva, Trichodermil FS® propõe acabar com o mal pela raiz

No agronegócio, cada safra começa antes mesmo da germinação. O que acontece debaixo da terra define o futuro de produtividade, sanidade e rentabilidade da lavoura. É nesse ponto crítico que a Koppert apresenta uma inovação inédita no mundo: o Trichodermil FS®, primeiro biofungicida e bionematicida com formulação exclusiva para tratamento de sementes à base de Trichoderma asperelloides.
Com o novo produto, a Koppert sugere “acabar com o mal pela raiz”, garantindo o futuro da colheita ainda sob a terra. Isso porque o Trichodermil FS® atua logo no início do ciclo, protegendo o sistema radicular contra fungos

de solo e nematoides, dois dos principais vilões que comprometem a produtividade de culturas como soja e milho, por exemplo.
Seu grande diferencial está na combinação da já conhecida cepa Trichoderma asperelloides ESALQ 1306 com a tecnologia FS (Flowable Concentrate for Seed Treatment). O resultado é uma formulação de alta estabilidade e compatibilidade, que proporciona secagem rápida, baixa dosagem e excelente desempenho em condições reais de campo. Para o agricultor, isso significa mais praticidade e segurança no investimento.
Do ponto de vista biológico, o Trichodermil FS® atua em múltiplas frentes, garantindo eficácia no controle de patógenos de solo e nematoides, além de promover o crescimento saudável das plantas.
Já na fase de germinação da semente tratada, a cepa coloniza rapidamente a rizosfera da planta, competindo por espaço e nutrientes com demais microrganismo. Nesse processo, ela secreta metabólitos capazes de inibir patógenos, atuando como microparasita sobre fungos causadores de doenças. Ao mesmo tempo, estimula o sistema de defesa natural da planta, fortalecendo sua resistência contra futuros estresses bióticos.
Estudos apontam que doenças de solo como Macrophomina, Fusarium e Rhizoctonia, além do complexo de nematoides, podem representar perdas de até 20% da produtividade por hectare, segundo a Embrapa (Empresa Brasileira de
Koppert: Trichodermil FS® atua logo no início do ciclo, protegendo o sistema radicular contra fungos de solo e nematoides
Pesquisa Agropecuária). Por essa razão, soluções como o novo produto da Koppert se torna estratégica não apenas para reduzir riscos, mas para sustentar o crescimento do setor.
EXPECTATIVAS PARA O SETOR
O Trichodermil FS® acompanha um movimento crescente do mercado brasileiro em busca de alternativas sustentáveis no combate de doenças de solo. De acordo com a CropLife Brasil, a adoção de bioinsumos cresceu mais de 10% nas últimas quatro safras, com destaque para a soja, que já responde por 62% das aplicações.
“O Trichodermil® (Trichoderma harzianum 1306), lançado em 2007, é um produto símbolo da Koppert no Brasil e responsável por abrir caminhos para o controle biológico em larga escala na agricultura tropical”, afirma o diretor industrial da Koppert América do Sul, Danilo Pedrazzoli. “Agora, com o Trichodermil FS®, damos um novo passo, alinhado à nossa estratégia de crescimento e à missão de tornar as lavouras mais produtivas, sustentáveis e economicamente viáveis, do pequeno produtor ao grande agricultor”, completa.
Por Amauri Segalla
Desde julho de 2016, quando a primeira edição foi lançada, a revista PLANT PROJECT acompanha de perto uma das transformações mais profundas da história recente do Brasil: a do agronegócio. Nesse período, o campo deixou de ser visto apenas como fornecedor de commodities para consolidar-se como potência global em inovação e sustentabilidade, além de exercer um protagonismo econômico que o coloca no centro das grandes discussões sobre o futuro do planeta. Agora, ao completar 50 edições, PLANT celebra não apenas a sua própria trajetória, mas também a do agro brasileiro, cada vez mais essencial para a vida no século 21.
Mais do que uma revista, PLANT PROJECT consolidou-se como a principal plataforma de comunicação do agronegócio no País. Desenvolvida em parceria com a DATAGRO, uma das maiores consultorias agrícolas do Brasil, PLANT oferece conteúdo de qualidade em múltiplos canais – revista impressa e digital, webséries, site, eventos e redes sociais –, sempre com a missão de ser um espaço permanente de troca de conhecimento e divulgação de informações indispensáveis para todos os protagonistas do setor.
Ao longo de 50 edições, PLANT foi testemunha e narradora das grandes mudanças que moldaram o agro contemporâneo: a digitalização do campo, a profissionalização da gestão, a sofisticação do financiamento rural, a valoriza-
ção da rastreabilidade e da bioeconomia, a entrada definitiva do agro na agenda climática e a ascensão das agtechs. Também registrou a emergência de uma nova geração de produtores, mais diversos e conectados, que carrega a responsabilidade de liderar a transição para um modelo produtivo sustentável.
Para comemorar a marca histórica, preparamos uma edição especial que reflete o passado recente, mas sobretudo lança luz sobre o futuro. Nela, contamos a história do Brasil que alimenta o mundo e se consolida como potência estratégica para a segurança alimentar global; mostramos como a inteligência digital está revolucionando a agricultura de dados; acompanhamos a virada verde que transformou práticas sustentáveis em rotina de milhares de produtores; revelamos como o crédito verde se tornou uma nova moeda para o agronegócio; e, por fim, conversamos com leitores que colecionam todas as edições da PLANT e que aceitaram dividir a memória dessa caminhada.
Chegar a 50 edições é, antes de tudo, a confirmação de que PLANT PROJECT se tornou referência indispensável para quem acredita que o agro brasileiro tem força para transformar o mundo. E é também a certeza de que continuará, edição após edição, cumprindo sua missão de dar voz aos protagonistas, estimular o diálogo e lançar luz sobre os caminhos que conectam o campo às grandes questões globais do nosso tempo.





































DESDE 2016, O AGRONEGÓCIO BRASILEIRO AMPLIOU SUA PARTICIPAÇÃO NO PIB, SUSTENTOU O COMÉRCIO
EXTERIOR EM TEMPOS DE CRISE E PASSOU A ALIMENTAR 1 BILHÃO DE PESSOAS NO MUNDO, EM UMA TRAJETÓRIA
QUE A PLANT PROJECT AJUDOU A CONTAR
Por Amauri Segalla

Nos últimos anos, o agronegócio brasileiro deixou de ser apenas um pilar importante da economia para se consolidar como alicerce fundamental do Produto Interno Bruto (PIB) do País. Em momentos de instabilidade, foi o setor que sustentou as contas externas, garantiu superávits comerciais e ajudou a preservar empregos. Se até pouco tempo atrás ainda pairavam dúvidas sobre a capacidade de o agro sustentar taxas consistentes de crescimento, hoje não há espaço para hesitação: a pujança do campo é parte indissociável da prosperidade nacional e, cada vez mais, também responsável por alimentar o mundo.
A revista PLANT PROJECT acompanhou cada passo dessa transformação. Desde sua estreia, em julho de 2016, trouxe às páginas, com profundidade e clareza, dados, entrevistas e análises que revelam a força crescente de um setor que passou a influenciar de maneira decisiva os rumos da economia brasileira. Mais do que registrar números, a PLANT mostrou como o Brasil se afirma como potência global de alimentos. Hoje, o agro brasileiro alimenta 1 bilhão de pessoas no mundo e responde sozinho por quase 55% das exportações mundiais de soja, 35% do comércio internacional de carne de frango e quase 25% das vendas de carne bovina. É uma força que projeta o País como peça central da segurança alimentar mundial.
A comparação com uma década atrás não poderia ser mais eloquente. Em 2016, o agronegócio representava 21% do PIB brasileiro, segundo dados da Confederação da Agricultura e Pecuária do Brasil e do Cepea/Esalq-USP. Em 2024, essa participação chegou a 27%, mesmo com o crescimento de outros segmentos da economia. Em valores absolutos, trata-se de
uma expansão impressionante: o PIB do agro saltou de R$ 1,4 trilhão para quase R$ 2,6 trilhões nesse período, quase dobrando em dez anos. A agricultura e a pecuária foram decisivas para manter a economia em movimento durante a recessão de 2015 e 2016, bem como na crise gerada pela pandemia da Covid-19, em 2020. Nos dois momentos, enquanto setores urbanos recuavam, o campo sustentou o PIB, manteve as exportações em alta e garantiu superávit à balança comercial.
Os números do comércio exterior ilustram a centralidade do agro na economia nacional e na alimentação mundial. Em 2016, o agronegócio brasileiro exportou US$ 85 bilhões, representando aproximadamente 45% do total das vendas do País ao mercado internacional. Em 2024, o valor saltou para US$ 164 bilhões, equivalentes a quase 50% do total de exportações do País. Soja, carnes, açúcar, celulose e café continuam como protagonistas, mas houve diversificação da pauta: etanol, algodão, frutas e até produtos de maior valor agregado passaram a ter espaço maior no mercado internacional. O resultado, ressalte-se mais uma vez, foi fundamental para que o Brasil acumulasse superávits comerciais expressivos, mesmo em anos em que a indústria e os serviços não conseguiram sustentar a mesma performance. O setor tornou-se, assim, a principal âncora da economia, mas também um dos maiores fornecedores globais de alimentos.
Outro traço marcante dessa década foi o salto de produtividade. A chamada segunda revolução verde no Brasil, apoiada em ciência, inovação genética, mecanização e agricultura digital, permitiu ampliar a produção sem avançar na mesma proporção sobre novas áreas. Entre 2016 e 2025, a produção de grãos
cresceu de 195 milhões para 330 milhões de toneladas, um aumento de quase 70%. A área plantada, porém, expandiu-se em ritmo bem mais modesto – de 60 para 80 milhões de hectares, segundo a Conab. Ou seja, a produtividade média por hectare avançou de maneira expressiva, o que se deve sobretudo ao uso de sementes mais eficientes, à modernização do manejo e à adoção crescente de tecnologias no campo.
O dinamismo do agronegócio se reflete na geração de empregos. O setor responde hoje por cerca de 30% das vagas formais do País. Não se trata apenas de trabalho no campo, mas também de empregos criados em indústrias de processamento de alimentos, no transporte, na logística e nos serviços associados. Um efeito visível é a interiorização da riqueza. Cidades do interior de Mato Grosso, Goiás, Bahia, Tocantins e Maranhão experimentaram um crescimento acelerado, com índices de desenvolvimento acima da média nacional. Universidades e centros de pesquisa foram instalados, redes de infraestrutura se expandiram e novos polos de inovação surgiram em regiões antes consideradas periféricas.
Como se não bastasse, nos últimos dez anos o Brasil deixou de ser visto apenas como celeiro de commodities para consolidar-se também como hub de inovação no agro. Startups de biotecnologia, plataformas digitais de gestão de fazendas e tecnologias de agricultura de precisão criaram um ecossistema vibrante, que atraiu investimentos de capital de risco e colocou o País no mapa das agtechs. Ao mesmo tempo, avançou a industrialização do campo. O processamento local de carnes, grãos e frutas gerou cadeias de valor mais
robustas, com maior geração de divisas. Grandes cooperativas, antes restritas ao fornecimento de insumos e ao escoamento da produção, se tornaram conglomerados industriais capazes de competir globalmente.
A força do agro ficou evidente nos momentos mais críticos. Durante a pandemia, em 2020, enquanto a indústria de transformação recuava 5%, o agronegócio avançou 3%. Anos depois, em 2022 e 2023, em meio a turbulências políticas e fiscais, o setor garantiu superávits recordes que ajudaram a estabilizar o câmbio e conter a inflação. A capacidade de atravessar crises, internas ou externas, confirma o peso crescente do agro na economia brasileira. Ao gerar divisas e manter as contas externas em equilíbrio, o setor atua como amortecedor em tempos de instabilidade e se firma como uma das bases mais sólidas para o desenvolvimento do País.
Se o balanço da última década é amplamente positivo, os próximos anos trarão desafios ainda maiores. O aumento da produtividade terá de caminhar lado a lado com a sustentabilidade, em um cenário marcado por exigências regulatórias mais rigorosas e consumidores internacionais cada vez mais atentos à origem dos alimentos que consomem. Práticas de baixo carbono, rastreabilidade e certificações ambientais já são condição de acesso a mercados estratégicos. Ao mesmo tempo, o setor terá de manter o ciclo de investimentos em inovação, infraestrutura e formação de capital humano no campo, para consolidar os avanços conquistados e ampliar sua competitividade. É esse novo capítulo que a PLANT PROJECT seguirá de perto, registrando como o Brasil pretende conciliar sua vocação agrícola com as demandas de um mundo em transformação.


SENSORES, ALGORITMOS E INTELIGÊNCIA ARTIFICIAL TRANSFORMARAM O AGRO EM UM CAMPO DE DECISÕES
INTELIGENTES, AUMENTANDO A PRODUTIVIDADE, REDUZINDO CUSTOS E PROJETANDO O BRASIL COMO POTÊNCIA AGROAMBIENTAL
Até pouco tempo atrás, a ideia de que o campo poderia se transformar em um ambiente de decisões inteligentes parecia algo distante, quase território da ficção científica. Na prática, predominava a lógica da intuição, da experiência acumulada e do olho treinado para interpretar sinais da natureza. Mas a chegada de sensores, drones, softwares de gestão e dados em tempo real mudou radicalmente esse cenário. Hoje, o campo brasileiro é um laboratório vivo da chamada agricultura digital, em que cada decisão de plantio, colheita ou manejo do rebanho pode ser apoiada em informações precisas.
A PLANT PROJECT, desde sua primeira edição, registrou essa virada histórica. Quando surgiram as primeiras plataformas de monitoramento de lavouras, há uma década, a revista foi pioneira em mostrar como agricultores do Cerrado passavam a contar com mapas digitais para acompanhar a umidade do solo, prever pragas e calcular doses exatas de fertilizantes. O que era novidade para alguns poucos logo se tornou rotina em pequenas propriedades familiares e em gigantes do agronegócio.
De lá para cá, o salto foi impressionante. Drones sobrevoam áreas de soja, cana e algodão, coletando imagens que são transformadas em relatórios detalhados em minutos. Máquinas agrícolas conectadas enviam dados em tempo real para centrais de controle. Plataformas digitais permitem que o produtor acompanhe cada talhão da fazenda pelo celular. Se a semente não germinou em determinada área, o alerta aparece na tela. Se uma praga ameaça se espalhar, o algoritmo sugere a aplicação localizada, evitando desperdícios. Na nova era, a lógica do “achismo” cedeu lugar ao manejo de precisão.
Some-se a isso a chegada da inteligência artificial ao agronegócio e o que se tem é uma revolução sem precedentes. Se sensores e softwares já permitiam coletar e organizar informações, a IA deu um passo além – ela passou a interpretar dados de maneira autônoma, aprender padrões e sugerir ações. Hoje, não é exagero dizer que a inteligência artificial se
tornou parte do cotidiano no campo. Plataformas de recomendação analisam variáveis climáticas e orientam o melhor momento de plantar, reduzindo riscos de perda por estiagens ou chuvas inesperadas. Algoritmos de visão computacional, embarcados em drones, identificam doenças em folhas ainda em estágio inicial, permitindo que o agricultor aja antes que o problema se espalhe.
A PLANT PROJECT foi testemunha privilegiada dessa transformação. Ainda em 2018, a revista destacou o caso da Solinftec, empresa brasileira que se tornou referência global em automação e IA para o agro. Suas soluções permitem integrar tratores, colheitadeiras e pulverizadores em uma rede inteligente, que se comunica em tempo real para reduzir sobreposição de insumos e otimizar a operação de máquinas. Hoje, a empresa opera em milhões de hectares no Brasil, nos Estados Unidos e em outros países, levando a tecnologia desenvolvida no interior de São Paulo para o mundo. Outro exemplo vem da @Tech, startup que usa inteligência artificial para monitorar o ganho de peso do gado em tempo real. Câmeras instaladas nos currais captam imagens do rebanho e, por meio de algoritmos de aprendizado de máquina, calculam automaticamente o peso dos animais sem necessidade de balança. O resultado é ganho de eficiência, redução de estresse para o gado e decisões mais rápidas sobre o momento ideal de venda.
A inteligência artificial não se limita ao espaço da fazenda. Na logística, algoritmos já ajudam a prever gargalos no transporte de grãos e carnes, simulando cenários e propondo rotas mais rápidas e baratas. Na comercialização, plataformas digitais apoiadas por IA analisam tendências de mercado, consumo e preços futuros, orientando produtores sobre o melhor momento de vender sua safra. No setor sucroenergético, por exemplo, usinas de cana-de-açúcar adotaram sistemas que monitoram desde a colheita até o processo industrial. Algoritmos calculam a rota mais eficiente para caminhões, evitando filas e desperdícios de cana cortada, e controlam variáveis de moagem em tempo real para aumentar o rendimento do etanol. A cadeia
de suprimentos também mudou. Empresas de fertilizantes e defensivos criaram plataformas que, com base em inteligência artificial, recomendam produtos e doses ideais para cada talhão de lavoura. É um círculo virtuoso: o agricultor economiza, reduz impactos ambientais e aumenta a produtividade. Um aspecto marcante da revolução digital é que ela não se restringe aos gigantes do setor. Cada vez mais, pequenas propriedades familiares adotam soluções digitais. A disseminação de aplicativos de baixo custo permitiu que agricultores de poucas dezenas de hectares tenham acesso às mesmas ferramentas de monitoramento usadas por fazendas de milhares de hectares. A PLANT PROJECT mostrou isso em reportagens que revelaram como a disseminação da tecnologia fez com que cidades inteiras se transformassem em polos de inovação. Hoje, municípios do interior do País têm hubs digitais que conectam pequenos agricultores a investidores, universidades e multinacionais. Os números dão a medida do impacto. Segundo a Embrapa, propriedades que utilizam tecnologias digitais de monitoramento e análise chegaram a reduzir em até 20% o uso de defensivos agrícolas, sem perda de produtividade. Em alguns casos, a economia de fertilizantes alcançou 15%, com ganhos diretos para o bolso do produtor e para o meio ambiente. Casos concretos ajudam a traduzir esse impacto. A Agrosmart combina sensores de campo, imagens de satélite e IA para oferecer recomendações personalizadas de irrigação. Em propriedades de café, o uso da ferramenta reduziu
em 50% o consumo de água, além de aumentar a produtividade. A ConnectFarm integra dados de máquinas, clima e mercado, gerando relatórios preditivos sobre custos e margens. Em fazendas de soja, a empresa ajudou produtores a definir o melhor momento de venda, aumentando a rentabilidade. A Embrapa, por sua vez, desenvolveu em parceria com universidades algoritmos que identificam estresse em bovinos, analisando imagens de câmeras instaladas nos currais. O sistema permite melhorar o bem-estar animal e reduzir perdas.
Se a agricultura 4.0 representou a primeira revolução digital do campo, a integração plena da inteligência artificial promete uma segunda onda, ainda mais profunda. As próximas fronteiras incluem o uso de modelos virtuais que simulam a fazenda inteira e permitem testar cenários antes de aplicá-los na prática, além do avanço da robotização autônoma, em que tratores e colheitadeiras operam sem condutores, guiados por IA e GPS. Outro campo em rápida expansão é o da genômica orientada por IA. Startups já trabalham em plataformas capazes de cruzar dados genéticos de plantas com informações climáticas e de solo, acelerando o desenvolvimento de sementes resistentes a pragas, secas e doenças. Para o Brasil, a revolução da inteligência artificial no campo significa mais do que ganhos de produtividade. Representa a possibilidade de consolidar o País como potência agroambiental, capaz de produzir em larga escala e, ao mesmo tempo, reduzir impactos ambientais.

O AGRO BRASILEIRO CONSOLIDA PRÁTICAS
SUSTENTÁVEIS E SE AFIRMA COMO PEÇA-CHAVE NA TRANSIÇÃO PARA UMA ECONOMIA DE BAIXO CARBONO

Ocampo brasileiro, tantas vezes visto como vilão ambiental, começa a ocupar um novo lugar no debate global: o de protagonista da transição para uma economia de baixo carbono. A adoção crescente de sistemas integrados, o manejo regenerativo e o avanço dos biocombustíveis mostram que a agenda verde deixou de ser promessa e se consolidou como prática cotidiana.
Desde o seu nascimento, a PLANT PROJECT acompanha de perto esse movimento. Nas reportagens sobre a adoção de sistemas integrados de produção até nos dossiês mais recentes sobre biocombustíveis, a revista vem mostrando como o campo brasileiro soube reinventar sua relação com o meio ambiente. Em suas páginas, ficou registrado que é possível produzir mais alimentos, fibras e energia com menor impacto ambiental. O que antes parecia utopia agora é rotina em milhares de propriedades espalhadas pelo País.
Um dos símbolos mais visíveis dessa transição é a expansão da Integração Lavoura-Pecuária-Floresta (ILPF). A prática, que combina diferentes sistemas produtivos em uma mesma área, tornou-se referência de sustentabilidade aplicada ao campo. Segundo a Embrapa, já são mais de 20 milhões de hectares adotando o modelo em diferentes regiões. Os resultados falam por si: aumento da produtividade, recuperação de áreas degradadas, maior fixação de carbono no solo e diversificação de renda para o produtor. Em diversas regiões brasileiras, fazendas que migraram para o sistema integrado conseguiram dobrar a lotação de gado por hectare, ao mesmo tempo que reduziram a necessidade de abrir novas áreas de pastagem. Além disso, áreas antes improdutivas voltaram a gerar renda com a introdução de florestas comerciais associadas ao cultivo de grãos.
O manejo regenerativo de pastagens é outra face da virada verde. Durante décadas, a pecuária brasileira conviveu com a imagem de pastos degradados e baixa eficiência. Hoje, a adoção de práticas regenerativas vem alterando essa equação.
O uso de adubação correta, a rotação de áreas, a introdução de espécies forrageiras mais resistentes e o manejo racional do gado elevaram significativamente a produtividade do setor. O impacto ambiental também é evidente: menos pressão sobre a abertura de novas áreas e maior capacidade de sequestro de carbono. Em várias regiões, iniciativas de pecuária de baixo carbono se tornaram vitrine para mercados internacionais, ansiosos por comprar carne certificada como proveniente de sistemas ambientalmente responsáveis.
Esse processo se conecta diretamente com a valorização da rastreabilidade. Se antes era suficiente oferecer volume e preço competitivo, hoje os compradores globais querem saber a história completa de cada lote de soja, café ou carne. De onde veio? Qual foi o impacto ambiental da produção? Houve respeito à legislação trabalhista? A resposta a essas perguntas está cada vez mais disponível em plataformas digitais que registram, passo a passo, a jornada dos alimentos.
Grandes tradings já condicionam contratos à comprovação de rastreabilidade socioambiental. A soja brasileira, por exemplo, passou a ser monitorada via satélite para garantir que não haja vínculo com áreas de desmatamento ilegal. A carne bovina destinada à Europa precisa vir acompanhada de certificados de origem e práticas de baixo carbono. O agro brasileiro, que sempre buscou competitividade pela escala, agora encontra nos selos e certificações um novo passaporte para se manter relevante nos mercados mais exigentes.
Outro movimento que caracteriza a virada verde é a busca por carbono neutro. Iniciativas de neutralização ou redução drástica das emissões passaram a integrar o planejamento estratégico de grupos agroindustriais e, em alguns casos, até de pequenos produtores organizados em cooperativas. O conceito de “fazenda carbono neutro” deixou de ser uma ideia distante para se tornar meta empresarial. Cooperativas de leite já contabilizam emissões e adotam práticas de compensação,
enquanto iniciativas de reflorestamento atreladas à produção de grãos vêm garantindo créditos de carbono que podem ser negociados em bolsas internacionais. No setor sucroenergético, algumas usinas assumiram o compromisso de neutralizar todas as suas emissões até 2030, combinando aumento de eficiência industrial com investimento em florestas energéticas.
Mas a virada verde do agro não se limita à produção de alimentos. Cada vez mais, o campo brasileiro se afirma como fornecedor estratégico de energia limpa. A história começou com o etanol de cana-de-açúcar, símbolo da matriz renovável brasileira. Nos últimos anos, ganhou força o etanol de milho, cuja produção passou de apenas 800 milhões de litros em 2015 para mais de 6 bilhões de litros em 2024, segundo a União Nacional do Etanol de Milho (Unem). O combustível não apenas diversificou a oferta como também transformou estados como Mato Grosso e Goiás em polos bioenergéticos, com plantas industriais que integram a produção de grãos, etanol, DDG (coproduto usado na alimentação animal) e geração de energia elétrica a partir da biomassa. O biodiesel seguiu a mesma trilha, consolidando-se como alternativa renovável ao diesel fóssil. O Brasil já adiciona 14% de biodiesel ao diesel comercializado, e a meta é ampliar essa mistura nos próximos anos. A produção se apoia sobretudo em soja e óleo de palma, mas pesquisas avançam para diversificar as matérias-primas, como macaúba e outras oleaginosas nativas, que prometem ampliar a escala sem pressionar a fronteira agrícola.
Ainda mais recentes, mas em crescimento acelerado, estão o biogás e o biometano. A transformação de resíduos da agroindústria em energia se tornou um filão competitivo. Em unidades de suinocultura no Sul, de cana-de-açúcar no Sudeste e de confinamentos de gado no Centro-Oeste, biodigestores passaram a captar metano e convertê-lo em eletricidade ou combustível veicular. Essa
prática fecha um ciclo virtuoso: reduz emissões, gera energia limpa e cria uma nova fonte de receita para o produtor. Estima-se que, apenas com o aproveitamento dos dejetos da pecuária, seria possível substituir até 30% do consumo de diesel agrícola do Brasil.
Nesse mesmo caminho da economia circular, o aproveitamento de coprodutos da agroindústria ganhou relevância. O bagaço da cana, que antes era resíduo, virou insumo para geração elétrica. Cascas e polpas de frutas passaram a ser usadas em rações ou na indústria química. A palha do arroz alimenta caldeiras de geração térmica em algumas regiões. Cada vez mais, nada se perde: tudo se transforma em alimento, energia ou insumo para novos processos industriais.
Ao longo de sua história, a PLANT PROJECT antecipou muitas dessas tendências. Ainda em 2017, a revista destacou pioneiros da integração lavoura-pecuária-floresta no Centro-Oeste. Em 2019, mostrou como startups de rastreabilidade digital começavam a conectar o campo a mercados globais de nicho. Em 2020, publicou reportagens sobre o crescimento do biogás e do biometano e sobre os planos de grandes cooperativas do Sul para adotar metas de carbono neutro. O tempo confirmou: não eram apenas boas histórias, mas sinais de um movimento estrutural.
A virada verde do agro brasileiro é, ao mesmo tempo, um desafio e uma oportunidade. Desafio porque exige investimentos contínuos, mudanças culturais e adaptação a marcos regulatórios cada vez mais rigorosos. Oportunidade porque coloca o Brasil na vanguarda de um novo paradigma: o de produzir em larga escala e, ao mesmo tempo, atender às demandas de sustentabilidade global. A edição número 50 da PLANT PROJECT registra esse momento singular: a transição definitiva de um agro que aprendeu a se reinventar para permanecer no centro da prosperidade nacional e, cada vez mais, na linha de frente da sustentabilidade mundial.

O CAMPO BRASILEIRO TRANSFORMA PRÁTICAS
AMBIENTAIS EM ATIVOS FINANCEIROS E CONSOLIDA
SEU PAPEL NA TRANSIÇÃO PARA UMA ECONOMIA DE BAIXO CARBONO
Por Amauri Segalla

Apaisagem financeira do agronegócio brasileiro está em transformação. Nos bancos, nas cooperativas e nos grandes eventos do setor, o crédito rural já não é visto apenas como recurso para custear a próxima safra. O debate agora inclui instrumentos que dão valor econômico ao que antes era invisível: a floresta preservada, o carbono que deixa de ser emitido, a água que permanece no solo. Nesse contexto, surgem os chamados créditos verdes, uma nova moeda que transforma boas práticas ambientais em ativos financeiros. Mais do que tendência passageira, é uma mudança estrutural que projeta o campo brasileiro como protagonista da transição para a economia de baixo carbono.
PLANT PROJECT tem acompanhado essa mudança com lupa. Desde as primeiras reportagens sobre mercados de carbono até as análises mais recentes sobre finanças sustentáveis, a revista vem mostrando como práticas ambientais deixaram de ser promessa para se afirmar como valor econômico real no campo. Essa trajetória, registrada ao longo de diversas edições, revela o quanto o crédito verde avançou em poucos anos, de ideia incipiente a realidade concreta em diferentes cadeias produtivas.
A sustentabilidade, antes percebida como obrigação, começa a ser encarada como oportunidade. Até pouco tempo atrás, o produtor preservava áreas de mata nativa porque a lei exigia, adotava boas práticas para manter acesso a mercados externos e cumpria protocolos ambientais para não perder contratos. Agora, a lógica se inverteu: cada hectare preservado, cada tonelada de carbono evitada e cada inovação sustentável podem ser monetizados, negociados em bolsa ou convertidos em crédito mais barato. É uma mudança de conceito que começa a redesenhar tanto o cotidiano das fazendas quanto as estratégias de investimento das grandes empresas do agro.
Esse movimento se espalha em três direções principais. A primeira é o mercado de créditos de carbono, que amadureceu no Brasil a ponto de se tornar alternativa concreta para agricultores e pecuaristas. Hoje, projetos de recuperação de pastagens degradadas, Integração Lavoura-Pecuária-Floresta (ILPF) e expansão de bioenergia já são
auditados e certificados para gerar créditos que podem ser vendidos em mercados voluntários ou regulados. O potencial é imenso: a Confederação da Agricultura e Pecuária do Brasil (CNA) estima que apenas com recuperação de pastagens o País poderia gerar até 1,5 bilhão de toneladas de CO₂ equivalente (CO₂e) em créditos até 2030.
A segunda frente é o avanço dos green bonds, títulos emitidos no mercado financeiro para financiar projetos sustentáveis. Segundo a Climate Bonds Initiative, o Brasil já soma mais de US$ 20 bilhões em emissões de títulos rotulados como verdes, sociais ou sustentáveis, e parte crescente desse montante tem origem em cadeias do agronegócio. Empresas sucroenergéticas, gigantes do papel e celulose, cooperativas de grãos e até frigoríficos começam a captar recursos com esse selo. Para investidores internacionais, funciona como um certificado de confiança que garante que o capital financia projetos capazes de reduzir emissões, preservar recursos hídricos e ampliar a eficiência energética.
A terceira dimensão está nas linhas de financiamento atreladas a critérios ESG. No Plano Safra 2024/25, por exemplo, o governo federal reservou quase R$ 10 bilhões para programas como o ABC+, voltados a práticas de baixa emissão de carbono. Bancos privados também criaram carteiras específicas que oferecem juros mais baixos e prazos maiores para produtores que comprovem a adoção de tecnologia sustentável. O resultado é um incentivo direto: investir em irrigação eficiente, bioinsumos ou energia solar na fazenda deixou de ser apenas um gasto de longo prazo e passou a gerar retorno imediato com o acesso a crédito mais barato.
Esse tripé – créditos de carbono, green bonds e financiamentos ESG – está redesenhando a posição do Brasil no mapa global da sustentabilidade. Em conferências internacionais, o País aparece cada vez menos como vilão ambiental e cada vez mais como peça-chave da descarbonização. Afinal, poucos lugares no mundo combinam tantas vantagens, como matriz energética limpa, agropecuária de escala, capacidade de inovação tecnológica e vastas áreas passíveis de recuperação.
A Embrapa calcula que a adoção de sistemas
integrados lavoura-pecuária-floresta já ocupa 18 milhões de hectares, com potencial para chegar a 35 milhões até 2030. Cada hectare nesse modelo gera ganhos ambientais mensuráveis e, ao mesmo tempo, aumenta a produtividade. A lógica é simples: quanto mais sustentável for a produção, mais competitiva ela se torna no novo ambiente econômico que valoriza métricas verdes.
Os casos se multiplicam. No setor sucroenergético, grupos como Raízen e São Martinho já estruturaram projetos que unem a venda de etanol de baixa emissão com a negociação de créditos de carbono gerados pelo uso do bagaço e da palha da cana como fonte de energia renovável. No Sul, cooperativas de leite criaram programas de rastreabilidade que garantem prêmios de exportação e acesso a linhas internacionais de financiamento verde. Entre os cafeicultores, certificações como Rainforest Alliance e Fairtrade abriram portas para operações de crédito específicas, além de posicionar o produto em mercados premium.
Até mesmo setores vistos como intensivos em emissões começam a se adaptar. Frigoríficos investem em programas de monitoramento de fornecedores para reduzir desmatamento indireto e, com isso, buscam emitir títulos verdes que financiem a transição da cadeia de pecuária bovina. Quem não se adequar ficará de fora não apenas dos mercados mais exigentes, mas também das fontes de financiamento mais baratas.
A monetização da sustentabilidade exige comprovação, e isso abre espaço para uma revolução tecnológica no campo. Drones sobrevo-
am lavouras para medir biomassa, satélites monitoram áreas preservadas, sensores coletam dados de uso da água e softwares integram informações em plataformas de rastreabilidade. Para acessar crédito verde, o produtor precisa apresentar evidências sólidas. E essa demanda estimula o surgimento de startups, consultorias e agtechs que transformam dados ambientais em relatórios auditáveis.
Apesar do entusiasmo, o caminho não está livre de obstáculos. A falta de padronização dos créditos de carbono ainda gera desconfiança em parte dos investidores. Questões regulatórias seguem em debate no Congresso e nos órgãos ambientais. A assimetria de informação entre grandes grupos e pequenos produtores ameaça aprofundar desigualdades no acesso às oportunidades. Além disso, há risco de “greenwashing”, quando práticas são rotuladas como sustentáveis sem comprovação real de impacto.
Mesmo assim, a tendência é de que recursos destinados ao financiamento verde cresçam em ritmo acelerado. Relatório recente da BloombergNEF mostra que o mercado global de títulos sustentáveis superou US$ 1,5 trilhão em 2024, e o Brasil figura entre os dez países com maior potencial de expansão. No presente e no futuro, cada vez mais o valor do agronegócio brasileiro será medido tanto pelo que sai da terra quanto pelo que se mantém em pé. Nessa equação, os créditos verdes surgem como a prova definitiva de que sustentabilidade e lucro podem andar lado a lado.
NA MARCA DE 50 EDIÇÕES, PLANT PROJECT REVELA O VÍNCULO
AFETIVO DE SEUS LEITORES E REFORÇA SEU PAPEL COMO REFERÊNCIA DE INFORMAÇÃO, CULTURA

Cristiane Andrade, da Helm: "As reportagens sobre inovação são as que chamam mais a atenção"
Por André Sollitto
Revistas nascem para serem lidas. Cumprindo sua missão, alcançam os leitores, informam com isenção, despertam curiosidades, revelam histórias essenciais e oferecem novos olhares sobre os temas que abordam. Algumas, porém, vão além: transformam-se em peças de colecionador. Depois da leitura, não são descartadas, mas guardadas com carinho, conquistando espaço especial nas estantes e bibliotecas. Chamam a atenção pelas capas marcantes, pelas lombadas coloridas e pelos assuntos que permanecem atuais. É nesse espírito que celebramos a 50ª edição da PLANT PROJECT – um marco para qualquer publicação impressa e, sobretudo, para um veículo dedicado à comunicação do agronegócio. Para comemorar, ouvimos nossos leitores, que revelaram uma conexão profunda e afetiva com a revista.
Uma das leitoras de longa data é Maria Jose Pirez Braga, jornalista que entrou no agro em 2010, ao integrar a equipe de um canal de TV especializado na cobertura do setor. O interesse virou paixão e, em 2016, ela deixou as redações para migrar para a comunicação corporativa. Hoje é gerente de Comunicação Externa da Basf Soluções para Agricultura na América Latina, onde atua no relacionamento com a imprensa, em treinamentos de comunicação e no acompanhamento de eventos. Com experiência nos
dois lados da informação – o jornalismo de redação e o corporativo –, Maria Jose lembra que a PLANT PROJECT chamou sua atenção desde os primeiros números. “Era um formato inovador, algo que eu ainda não tinha visto na comunicação do agro”, diz.
Assim como Maria Jose, outros profissionais também criaram laços com a revista a partir de suas experiências no setor. Cristiane Andrade conheceu a PLANT PROJECT por meio de sua trajetória profissional. Atualmente é coordenadora de Comunicação e Eventos da unidade de negócios Crop Solutions da Helm no Brasil, mas foi durante os vários anos em que trabalhou na Basf que entrou no universo agro – e também em contato com a revista. “Fui o contato responsável pela realização de projetos e anúncios, o que me inseriu diretamente no universo da publicação. A partir daí passei a receber a edição impressa regularmente, e foi uma grata surpresa”, afirma.
A influenciadora digital Aretuza Negri, criadora do perfil “Ela É do Agro”, conheceu a PLANT PROJECT enquanto buscava referências de conteúdo sobre o setor. Filha de um “canassauro”, como gosta de dizer, cresceu em meio à vida no campo e acabou levando essa vivência para a comunicação digital. Nas redes sociais, passou a contar histórias reais de pessoas e de seu impacto no agronegócio, construindo uma audiência fiel. Foi nesse contexto que se aproximou da revista. “Sempre me chamou a atenção a maneira como a PLANT entrega profundidade, cultura e estética, comunicando o agro de forma inspiradora e contemporânea”, afirma.
Cada leitor guarda na memória reportagens marcantes das 49 edições anteriores de PLANT PROJECT. Para Maria Jose, uma delas foi “Vinhos ao Mar”, publicada em novembro de 2021. “Fiquei encantada ao ler sobre a Bodega Oceánica José Ignacio, que guarda os vinhos no fundo do mar”, recorda. “Incrível a forma como foi escrita e o quanto deixa o leitor vidrado em conhecer e saber mais.” Já Cristiane Andrade destaca seu interesse pelo ecossistema de

Maria Braga, da Basf: "Plant tem um formato inovador, algo que eu não tinha visto no agro"
tecnologia no campo. “As reportagens que mais me chamam a atenção são aquelas que abordam iniciativas de inovação, como o trabalho da ACE Startups com a criação da AgroStart e a aceleração de agtechs”, afirma. Aretuza já foi personagem de uma reportagem da revista sobre influenciadores e criadores de conteúdo conectados à produção no campo – experiência que, naturalmente, está entre as mais marcantes para ela. Mas revela que o que mais aprecia são os textos que estabelecem pontes com as artes, o design e a inovação. “Eles mostram o setor para além da produção, como parte da cultura e da sociedade. Esses conteúdos sempre me lembram que comunicar o agro é também contar histórias

A influenciadora Aretuza Negri:
"Plant comunica o agro de forma inspiradora e contemporânea"
humanas e universais”, afirma. Ao longo de suas 50 edições, PLANT PROJECT publicou reportagens que transitam por economia e negócios, agronomia, tecnologia, artes, gastronomia e tantos outros temas, sempre com o propósito de aproximar o campo da cidade e mostrar a amplitude do agronegócio em suas múltiplas dimensões.
Para os leitores, a versão impressa da revista, publicada bimestralmente e enviada a um mailing de tomadores de decisão do setor, é parte essencial de seu encanto. “Publicações impressas são cada vez mais raras no mercado. Sempre digo que as que permanecem são aquelas que entregam um valor diferenciado, e vejo que a PLANT PROJECT oferece um
formato inovador, com visual moderno, diagramação impecável e conteúdo de qualidade”, afirma Maria Jose. Cristiane compartilha da mesma percepção. “Sou uma entusiasta da leitura em papel e valorizo o ritual de abrir a embalagem, sentir a textura das páginas e o cheiro característico do papel recém-impresso. O formato físico oferece uma experiência única”, diz.
Embora todo o conteúdo também esteja disponível em formato digital, no site da revista, a edição impressa oferece uma experiência distinta de leitura. “O papel representa uma pausa, uma forma diferente de se informar. Enquanto as redes sociais aceleram, a revista convida a desacelerar e permite absorver o conteúdo com mais profundidade e calma. Acredito que os dois formatos não competem, mas se complementam”, diz Aretuza Negri.
O propósito central de qualquer veículo de comunicação é informar. No caso do agronegócio brasileiro – responsável por uma fatia significativa do PIB do País –, informação de qualidade é ainda mais essencial. “Revistas como a PLANT PROJECT têm o objetivo de mostrar o agro de uma forma diferenciada, trazendo conteúdos relevantes, mas também curiosidades de várias partes do mundo. Precisamos de publicações assim para fortalecer a imagem do setor”, afirma Maria Jose.
Para Cristiane, o valor vai além da notícia. “A revista não é apenas um registro do presente: é também um material de consulta permanente, com um legado de conteúdo que permanece atual”, diz. “O poder duradouro do impresso é justamente esse: um acervo de conhecimento que transcende o tempo, sempre disponível para ser guardado, consultado e valorizado.” Aretuza divide a mesma visão. “Para mim, não é só colecionar uma revista, é colecionar uma história do agro contada de forma única. E confesso: cada nova edição que chega é recebida como um presente.”
Protagonismo
Moçambique emerge como nova potência agrícola da África, com terras férteis, acesso ao Oceano Índico e capital estrangeiro
As regiões produtoras do mundo

FRONTEIRA

As regiões produtoras do mundo

Por Alexandre Dantas
Aimagem que o mundo guarda de Moçambique ainda é a de um país marcado por contrastes profundos: uma natureza exuberante, instabilidade política e pobreza persistente. Na última década, porém, essa narrativa começou a mudar. Cada vez mais, Moçambique vem se projetando como uma das mais promissoras fronteiras agrícolas da África, um continente que, para além das crises, abriga também o maior potencial inexplorado de terras cultiváveis do planeta.
A população africana deve dobrar até 2050, alcançando 2,5 bilhões de habitantes. A pressão sobre a produção de alimentos será gigantesca, e poucos países reúnem condições tão favoráveis para liderar essa expansão quanto Moçambique.
Estima-se que 36 milhões de hectares de terras agricultáveis estejam disponíveis, mas apenas 16% são efetivamente utilizados. A água não é problema – o país é cortado por grandes rios e possui bacias hidrográficas capazes de irrigar vastas áreas. A localização também é estratégica. Com portos naturais voltados para o Oceano Índico, Moçambique tem acesso direto a mercados da Ásia e do Oriente Médio, cada vez mais dependentes de importações de alimentos.
O desafio moçambicano é transformar esse potencial em realidade. Durante 16 anos, a guerra civil (1977–1992) devastou o campo e afastou investimentos. A agricultura permaneceu basicamente de subsistência, centrada em culturas como mandioca, milho, feijão e amendoim. Só a partir dos anos 2000, com a pacificação e o avanço de programas internacionais de apoio ao desenvolvimento, o país começou a dar os primeiros passos para modernizar sua produção.
Projetos de cooperação bilateral tiveram papel central. O Brasil, por meio da Embrapa e da Fiocruz, desenvolveu experiências no chamado Corredor de Nacala, região ao norte do país com solo fértil e clima propício para soja, milho e algodão. O Japão, parceiro no mesmo projeto, financiou infraestrutura logística, incluindo a reabilitação da ferrovia que liga o interior ao porto de Nacala, no Oceano Índico. Foi nesse contexto que grandes produtores brasileiros de soja e algodão começaram a explorar áreas no país, enxergando ali uma oportunidade semelhante à abertura do Cerrado, que transformou o Brasil em potência agrícola.
A soja é o exemplo mais emblemático da ambição moçambicana de se firmar no mapa da agricultura global. Segundo a FAO, a produção local passou de 10 mil toneladas em 2005 para mais de 150 mil toneladas atualmente. Ainda é pouco se comparado ao Brasil ou aos Estados Unidos, mas o crescimento é expressivo. Com apoio de novas tecnologias – sementes adaptadas, manejo do solo e sistemas de rotação –, Moçambique já exporta soja para países vizinhos, como Malawi e Zimbábue, e ensaia os primeiros embarques para o mercado asiático.
O país não aposta apenas nos grãos, se destacando também na produção de cana-de-açúcar, tabaco e algodão, culturas tradicionais que hoje ganham novos mercados ligados à bioenergia e à indústria têxtil. Plantios de eucalipto no norte do país abastecem fábricas de celulose e papel, algumas voltadas exclusivamente para exportação.
A integração lavoura-pecuária também começa a surgir como modelo, impulsionada pela necessidade de recuperar pastagens degradadas e
Multinacionais agrícolas veem na região um mercado em expansão, pouco explorado e com possibilidade de crescimento rápido

aumentar a produtividade de carne e leite. Estima-se que a pecuária bovina moçambicana movimente hoje cerca de 1,5 milhão de cabeças, mas o potencial é muito maior, especialmente porque o país dispõe de áreas de pastagem equivalentes às do Centro-Oeste brasileiro.
Nenhuma fronteira agrícola floresce sem infraestrutura, e este talvez seja o maior desafio do país. A malha rodoviária é precária, as ferrovias ainda são insuficientes e a energia elétrica não chega a boa parte do interior. O Porto de Nacala, modernizado recentemente, é considerado um dos melhores da costa africana, mas ainda opera abaixo do potencial. Para competir globalmente, Moçambique precisa vencer o gargalo logístico. Nesse sentido, empresas e governos estrangeiros desempenham papel decisivo. A China já investe em estradas, pontes e usinas, e o Japão, por meio da Jica, segue apoiando o Corredor de Nacala.
Uma questão central na nova fronteira agrícola moçambicana é o impacto sobre os pequenos produtores. Mais de 70% da população ativa do país vive da agricultura de subsistência. A expansão de grandes empreendimentos pode gerar divisas e infraestrutura, mas também corre o risco de excluir famílias camponesas, concentrando terras e recursos. Há, portanto, uma tensão permanente entre dois modelos: o da agricultura empresarial de larga escala e o da agricultura familiar, responsável pela maior parte da segurança alimentar interna.
Alguns projetos tentam construir pontes entre esses dois mundos. O ProSavana busca transferir tecnologia para pequenos agricultores e integrá-los a cadeias de valor maiores. Embora tenha enfrentado críticas e resistência de movimentos sociais, a iniciativa tem servido para colocar em pauta a necessidade de políticas inclusivas, que permitam ao camponês acessar crédito, insumos e assistência técnica.
Nesse cenário, nos últimos anos os investidores passaram a olhar para o agro de Moçambique com crescente interesse. O Banco Mundial e o Banco Africano de Desenvolvimento classificam o país como estratégico para a segurança alimentar global, destinando linhas de crédito para ajudar a desenvolver a produção local. Empresas de sementes, fertilizantes e maquinário agrícola também têm desembolsado bom volume de recursos para instalar filiais, criar centros de distribuição e oferecer pacotes tecnológicos que vão desde o fornecimento de insumos até programas de treinamento de agricultores.
Multinacionais agrícolas veem na região um mercado em expansão, pouco explorado e com possibilidade de crescimento rápido, dada a combinação de terras férteis, mão de obra disponível e proximidade de grandes rotas comerciais. Se conseguir combinar grandes investimentos internacionais com políticas de apoio ao pequeno produtor, Moçambique poderá se firmar como uma potência agrícola em alguns anos.
Os tons do verde Festival antecipa a COP30 e celebra a força da música paraense na Amazônia
Um campo para o melhor da cultura

Um campo para o melhor da cultura
A COP em Belém abre caminho para que o Brasil e o mundo conheçam a riqueza e a diversidade da música paraense
CPor André Sollitto
omo prévia da COP30, um festival vai transformar a música em espaço de discussão sobre a preservação ambiental e a floresta amazônica. É o Amazônia Live, organizado pela mesma empresa que criou o Rock in Rio e o The Town, em São Paulo. A presença da estrela americana Mariah Carey atrai grande atenção: ela se apresentará em um palco flutuante em formato de vitória-régia, instalado sobre o Rio Guamá, em Belém. Poucos dias depois, será a vez de Ivete Sangalo subir ao palco, no Estádio do Mangueirão, também na capital paraense. Mas o festival reserva outras surpresas significativas. Antes de Mariah, um encontro raro reúne Dona Onete, Joelma, Gaby Amarantos e Zaynara, representando diferentes gerações da música do Pará. Já no mesmo dia de Ivete, Viviane Batidão divide a cena com o Lambateria Baile Show, comandado pelo guitarrista e produtor Félix Robatto, que recebe como convidada Lia Sophia, novo nome do carimbó. É uma celebração que coloca em evidência a vitalidade de uma das cenas musicais mais pulsantes do Brasil.
A tradição musical do Pará é tão antiga que sua origem se perde no tempo e não encontra registros escritos. No centro dessa história está o carimbó, ritmo de música e dança criado no século 17 pelos tupinambás, a partir de influências trazidas por negros escravizados no nordeste do estado. No Brasil Colônia, o gênero era marcado pela força da percussão, sobretudo dos carimbós ou curimbós, tambores que lhe deram nome. Com o passar das gerações, o ritmo ganhou novos timbres, das violas caboclas e flautas de madeira às guitarras, clarinetes e saxofones. “A importância desse instrumental envolve a própria definição estética, estilística e simbólica do carimbó, constituindo parte fundamental de sua sonoridade”, registra o documento que oficializou o gênero como forma de expressão e Patrimônio Cultural do Brasil, reconhecido pelo Iphan em 2014.
Mariah Carey vai se apresentar em um palco flutuante em formato de vitóriarégia, instalado sobre o Rio Guamá

Um traço marcante da cena cultural do pará é a capacidade de absorver influências externas e transformá-las em algo original

O auge veio nas décadas de 1970 e 1980, quando mestres como Pinduca, Cupijó e Verequete gravaram LPs que se tornaram preciosidades disputadas por colecionadores de vinil. Hoje, cópias em bom estado chegam a valer pequenas fortunas – um exemplar de Menina Chorona, de Mestre Cupijó, ultrapassa os R$ 700 na plataforma Discogs. O interesse internacional também cresceu: gravadoras especializadas no resgate de sonoridades dançantes, como a alemã Analog Africa, já dedicaram coletâneas inteiras ao carimbó.
Um dos traços mais marcantes da efervescência cultural e musical do Pará é a capacidade de absorver influências externas e transformá-las em algo genuinamente original. Foi assim com a lambada. Nos anos 1970, Pinduca, hoje com 88 anos, chegou a lançar uma canção com esse nome, mas sua sonoridade estava distante
do gênero que viria a surgir depois. O verdadeiro responsável pela consolidação do estilo foi o guitarrista e compositor Manoel Cordeiro, que combinou referências do carimbó, da cúmbia colombiana e do merengue caribenho para criar uma nova linguagem musical. “O que fazemos é música popular brasileira feita na Amazônia”, afirmou Cordeiro em entrevista ao jornalista Fernando Rosa, do portal Senhor F.
Reconhecido como um dos grandes articuladores da música amazônica, ele segue ativo, tendo participado recentemente de discos de artistas de outras regiões do país, como o BaianaSystem. Nos anos 1990, a lambada rompeu fronteiras locais e ganhou projeção nacional com o grupo Kaoma, que levou uma de suas canções para a trilha sonora da novela Rainha da Sucata, exibida pela Globo.
Da lambada nasceu outro gênero emble -





DEZ DISCOS ESSENCIAIS PARA MERGULHAR NA MÚSICA PARAENSE
Siriá, de Mestre Cupijó e seu Ritmo
Com ritmos dançantes, é uma coletânea feita pela gravadora alemã Analog Africa de pérolas do carimbó
Aldo Sena 1983, de Aldo Sena
O músico é um dos três principais nomes da guitarrada, responsável por algumas das mais emblemáticas composições do gênero
Manoel Cordeiro & Sonora Amazônia, de Manoel Cordeiro
Obra importante para entender a levada da lambada, criada pelo músico, mas também por seu virtuosismo como guitarrista
Banzeiro, de Dona Onete
Hoje com 86 anos, a cantora é reconhecida como Patrimônio Imaterial do Estado do Pará, e esse é seu disco mais importante
Tecnoshow, de Gaby Amarantos
Pedra fundamental do tecnobrega, mostra como as batidas eletrônicas renovaram os gêneros regionais
Uma noite amazônica, de Joelma
Lançado neste ano, é uma gravação ao vivo de um show que a cantora fez em Portugal, onde interpreta alguns de seus hits
Batidão Tropical Vol. 2, de Pabllo Vittar
Uma das cantoras mais populares do Brasil, mergulhou no repertório do tecnobrega, revitalizando grandes sucessos
Eletrocarimbó, de Lia Sophia
O trabalho de 2021 mostra uma das novas vozes responsáveis por manter a tradição do carimbó viva, mas com elementos contemporâneos
mático do Pará: a guitarrada, também chamada de lambada instrumental. Seu criador é reconhecido como Mestre Vieira (1934-2018), responsável por lançar o primeiro LP dedicado exclusivamente à guitarra, com composições que mesclavam referências paraenses e caribenhas. Entre as décadas de 1970 e 1980, a série de discos Guitarradas , lançada pela gravadora Gravasom – um dos selos fonográficos mais influentes da região – consolidou e popularizou o estilo. Ao lado de Vieira, nomes como o virtuose Aldo Sena e Mestre Curica formaram a tríade fundamental do gênero, que depois se renovaria com outros expoentes, como Chimbinha. Hoje, a guitarrada é reconhecida por sua sonoridade limpa, marcada pela guitarra sem distorção e pela cadência rítmica contagiante.
Como em uma linha do tempo musical, a sonoridade da guitarra herdada da lambada serviu de alicerce para o calypso. O caldeirão de ritmos paraenses recebeu novas camadas, como o calipso caribenho (com “i”) e até influências do reggae. Embora tenha surgido em meados da década de 1990, o gênero só alcançou projeção nacional nos anos 2000, impulsionado pelo estrondoso sucesso da Banda Calypso, seu principal expoente.
Criada pelo guitarrista Chimbinha e pela cantora Joelma, então sua esposa, a banda lançou o primeiro disco de forma independente e surpreendeu: vendeu mais de 500 mil cópias, conquistando o certificado de Platina. Eram tempos em que as mídias físicas ainda reinavam sobre o streaming, e o compartilhamento de CDs, aliado ao boca a boca, ajudou a espalhar o fenômeno. O sucesso abriu caminho para outras formações, como a Companhia do Calypso, que também surfaram na onda.
Tendo sempre os gêneros regionais e o carimbó como ponto de partida, uma nova geração de músicos adicionou outros elementos à mistura. Assim nasceram o tecnobrega e, mais tarde, o tecnomelody, que incorporaram
tecnologia, batidas eletrônicas, sintetizadores e AutoTune. O grupo pioneiro foi o Tecnoshow, liderado por Gaby Amarantos, cuja voz se tornou símbolo do movimento. As festas embaladas pelas famosas “aparelhagens de som” – herdeiras diretas dos sound systems jamaicanos – popularizaram o gênero primeiro nas periferias e, em seguida, nos maiores palcos do País.
Gaby é figura central dessa cena, especialmente após o sucesso de Ex Mai Love, em 2012, quando a canção entrou na trilha da novela Cheias de Charme e conquistou uma nova geração de ouvintes. Mas o movimento também revelou outros nomes importantes, como Gang do Eletro, Viviane Batidão e, mais recentemente, Banda Uó. Em 2023, o relançamento do disco Tecnoshow recebeu o Grammy Latino de Melhor Álbum de Música de Raízes em Língua Portuguesa e foi reconhecido como Patrimônio Cultural Imaterial do Pará pela Assembleia Legislativa. “O meu trabalho é fazer com que o nosso movimento seja reconhecido no Pará, no Brasil e no mundo todo”, disse Amarantos ao celebrar a conquista.
O tecnobrega vive hoje um momento de redescoberta. Pabllo Vittar ajudou a reavivar o gênero com os álbuns Batidão Tropical (2021) e Batidão Tropical Vol. 2 (2024), nos quais regravou sucessos de grupos como Banda Calypso e Companhia do Calypso, apresentando essas músicas a um público muito mais amplo. Joelma, por sua vez, voltou ao centro dos holofotes e passou a ser presença em grandes festivais, como o Rock the Mountain, em Petrópolis – movimento impulsionado pelo hit Voando pro Pará, que viralizou nas redes sociais. Até mesmo o The Town, tradicionalmente voltado ao rock e ao pop, abriu espaço para essa cena, incluindo artistas paraenses em sua programação como uma prévia do Amazônia Live. Na mesma Belém que receberá líderes mundiais para debater o futuro do planeta, a música se afirma como símbolo de vitalidade e de pertencimento.
Sotaque brasileiro Uísques nacionais ganham espaço com rótulos premiados e prestígio crescente © Shutterstock
A
grande feira mundial do estilo e do consumo

Embora a linha própria da Union seja recente – foi lançada apenas em 2020 –, a empresa está no mercado desde 1948
As regiões produtoras do mundo

Uísques nacionais ganham espaço com rótulos envelhecidos, técnicas artesanais e reconhecimento internacional, mostrando que o País tem muito a oferecer além do vinho e da cachaça
Por André Sollitto
No universo do uísque, alguns rótulos passam décadas repousando em barris de madeira, ganhando lentamente maturidade e complexidade. A maioria dessas preciosidades longamente envelhecidas vem da Escócia, berço do Scotch e referência mundial tanto em volume de produção quanto em tradição. O clima e a expertise secular escocesa ajudaram a consolidar esse prestígio, seguido de perto por países como Canadá, Irlanda, Japão e Estados Unidos, que também desenvolveram linhas premium. Agora, é a vez do Brasil entrar no seleto grupo. O Pure Malt Vintage 2005 Double Wood, recém-lançado, chega ao mercado com 20 anos de maturação – é um feito inédito no País. O rótulo integra o portfólio da Union Distillery, instalada no Vale dos Vinhedos, em Bento Gonçalves (RS), região reconhecida pelos vinhos, mas que começa a conquistar também espaço entre apreciadores de destilados.
Embora a linha própria da Union seja recente – foi lançada apenas em 2020 –, a empresa está no mercado desde 1948 e produz cevada maltada, a base do uísque, desde 1973. Durante décadas, a companhia atuou quase exclusivamente como fornecedora de matéria-prima para outros engarrafadores, que estampavam suas marcas no produto final. A aposta em rótulos autorais veio durante a pandemia, após anos dedicada ao trabalho para terceiros. “Nos últimos 20 anos houve um movimento de grandes marcas internacionais trazendo seus single malts para o mercado brasileiro”, afirma Luciano Borsato, diretor executivo da Union. “Identificamos uma oportunidade, lançamos nossos próprios produtos e abrimos nossa loja.”
O portfólio nasceu enxuto, com alguns rótulos clássicos, entre eles um blended produzido a partir da combinação de uísques de malte e de grãos, além de um puro malte, elaborado apenas com cevada maltada. O grande salto de reconhecimento veio com o lançamento do Extra Turfado, versão de sabor defumado que se tornou diferencial da marca. “Aquilo foi uma novidade e nos deu impulso, mesmo no auge da pandemia”, diz Borsato.
O sucesso do novo produto estimulou a destilaria a diversificar o portfólio. Vieram então rótulos que exploram técnicas típicas dos uísques artesanais, como a finalização em barris secundários após a maturação. Nesse processo, são utilizados barris virgens, que nunca receberam outra bebida, para aportar maior intensidade, ou recipientes que antes guardaram vinho, jerez ou cerveja do tipo Barley Wine, cada um conferindo características aromáticas e de sabor distintas.
Mais recentemente, a empresa apresentou a linha Vintage, dedicada a maturações prolongadas. É nela que se destaca o Vintage 2005, envelhecido por 17 anos em carvalho americano e mais três em carvalho francês, combinação que resulta em camadas diferentes de aromas. O engarrafamento ocorre a 50º de teor alcoólico, acima da média do mercado,
A Lamas, de Minas Gerais, construiu um portfólio variado que inclui versões com diferentes níveis de defumação
mas com justificativa técnica. No barril, a bebida atinge entre 60º e 62,5º, concentração considerada ideal para extrair sabores da madeira. Em alguns países, esse teor chega às prateleiras sob o nome de cask strength. No Brasil, a legislação impõe limite de 54º, o que obriga a diluição do destilado com água. “Essa diluição é necessária para dar equilíbrio à bebida”, explica Borsato.
As novidades ajudaram a formar um público de entusiastas dispostos a pagar mais para experimentar rótulos diferenciados. As linhas finalizadas em barris secundários custam entre R$ 225 e R$ 385, enquanto o Pure Malt Vintage 2005 chega a R$ 895. “Nossa venda é bastante direcionada. Trabalhamos com a loja física, a loja virtual e alguns empórios”, afirma Borsato. A destilaria também aposta no turismo para ampliar a visibilidade, oferecendo visitas guiadas que apresentam o processo de produção, percorrem a sala de barricas e terminam com uma degustação de quatro rótulos. O ingresso custa R$ 85 e inclui uma taça de lembrança. Como no vinho, a experiência turística se torna um aliado na difusão da bebida.
A Union não está sozinha no movimento de valorização dos uísques nacionais. Outro nome de destaque é a Lamas, de Minas Gerais,

A destilaria Geest lançou o inusitado El Miraculoso Calibrador, um uísque do tipo moonshine – que não foi envelhecido

que construiu um portfólio variado. A linha básica inclui um puro malte e um blended. Já a trufada oferece duas versões com diferentes níveis de defumação. Há ainda uma coleção especial, formada por rótulos finalizados em barris secundários ou inspirados em estilos consagrados, como o bourbon, produzido a partir de grãos. Instalado em um dos estados mais associados à cachaça, o alambique mineiro aproveita a tradição local e envelhece parte das bebidas em madeiras típicas do destilado de cana, como amburana e bálsamo. Algumas edições limitadas exploram ainda mais essa diversidade, como é o caso do rótulo maturado em putumuju, árvore nativa da Mata Atlântica (Centrolobium robustum). Já esgotada, a garrafa alcança até R$ 1,2 mil em plataformas online e se tornou objeto de desejo entre colecionadores.
Outras iniciativas também começam a se destacar. Em Minas Gerais, o uísque Arthur é
um single malt que reforça a diversidade da produção local. Já a destilaria Geest, em parceria com a cervejaria artesanal Juan Caloto, lançou o inusitado El Miraculoso Calibrador de Mira de Widowmaker Joe, um moonshine – tipo de uísque não envelhecido. Nos anos 1930, durante a Lei Seca nos Estados Unidos, esse destilado era produzido clandestinamente, geralmente em condições precárias, o que o transformou em sinônimo de bebida perigosa. Hoje, a realidade é outra: produtores artesanais vêm explorando o potencial do estilo, inclusive fora dos Estados Unidos. O rótulo da Geest conquistou reconhecimento inédito para o Brasil ao ganhar medalha de ouro e ser eleito o grande campeão da categoria New Make & Young Spirit no World Whiskies Award, um dos mais importantes eventos do setor. Ainda recente, o mercado brasileiro de uísque já demonstra vitalidade e sinais de que tem muito a revelar.
Ciência aplicada Pesquisas com edição genética abrem uma nova fronteira para o agro brasileiro
As inovações para o futuro da produção

As inovações para o futuro da produção
O USO DA EDIÇÃO GENÉTICA EM MICRORGANISMOS
PROMETE TRANSFORMAR A DEFESA DAS PLANTAS E IMPULSIONAR A PRODUTIVIDADE AGRÍCOLA
Por Romualdo Venâncio
Ouso da tecnologia de edição gênica CRISPR (Repetições Palindrômicas Curtas Agrupadas e Regularmente Interespaçadas) na agricultura nacional voltou a ser notícia. Após o impacto da novidade desenvolvida pelas cientistas Emmanuelle Charpentier e Jennifer Doudna, ganhadoras do Prêmio Nobel de Química no início desta década por tal feito, o tema tornou a ganhar destaque no Brasil devido, principalmente, a pesquisas feitas pela Embrapa que buscavam melhorar o desempenho de fungos utilizados no controle biológico de pragas e doenças agrícolas.
O objetivo dos estudos desenvolvidos com a edição gênica desses microrganismos pela unidade Embrapa Arroz e Feijão, localizada em Santo Antônio de Goiás (GO), é ampliar o leque de soluções que impulsionem o controle biológico de pragas e doenças. E, assim, contribuir para elevar índices de eficiência agronômica, ambiental e financeira das lavouras.
O trabalho vem sendo desenvolvido desde 2022, com foco em agentes de controle biológico e promotores de crescimento de plantas.
O primeiro impacto já no campo veio em 2024, a partir de uma linhagem editada do fungo Trichoderma harzianum, que apresenta potencial superior na produção de melanina, triplicando sua proteção, se comparada à cepa selvagem. Na lavoura, o resultado prático dessa característica é a maior estabilidade do agente biológico ao ser aplicado na parte aérea da planta, sob o sol, para o controle de doenças fúngicas.
“O boom dos microrganismos já surgiu há mais tempo, mas faltava algo como o que estamos trabalhando agora”, afirma o pesquisador da Embrapa e coordenador dos estudos, Marcio Côrtes.
Um dos grandes avanços nesses estudos é a garantia da autoproteção dos microrganismos à radiação solar, pois sofrem com a temperatura. A edição gênica permite que os cientistas garantam ao agente biológico seu
Um dos grandes avanços nos estudos recentes é a garantia de autoproteção dos microrganismos à radiação solar

próprio protetor solar, tornando-o mais eficiente e evitando assim o uso de uma opção artificial. “Estamos avançando muito rápido e, em breve, devemos ter algum produto no mercado”, diz Côrtes.
Segundo o pesquisador, a Embrapa trabalha com um grupo de 12 pesquisadores e um programa de bioinsumos. A empresa ainda aproveita as bases de pesquisas de suas diferentes unidades para usufruir de tudo o que for possível. Os estudos não partem do zero. “O mais importante é que lá na frente o produtor tenha um produto interessante para usar”, diz ele.
A pesquisa passa por um ponto crucial na transição entre experiência e realidade de mercado, que é o processo de avaliação e aprovação da Comissão Técnica Nacional de Biossegurança (CTNBio) por se tratar de um produto editado e não um transgênico. O resultado deve estar pronto no final deste ano. Essa definição faz toda a diferença para o microrganismo ganhar dimensões comerciais, pois é significativa a resistência do mercado
consumidor a alimentos e outros itens transgênicos.
Para o diretor de Pesquisa e Desenvolvimento e Inovação da Sempre AgTech, Hugo Molinari, os produtos dessa nova geração do melhoramento genético trazem uma combinação de fatores que os tornam bem mais aceitáveis. “Vêm com pegada muito mais inteligente, com modificações pontuais, mais precisas e um apelo bem mais sustentável. São considerados eco friendly”, diz. Segundo o executivo, a edição gênica proporciona um ganho institucional para o agronegócio brasileiro, com olhar para o setor e para as pessoas como um todo. “É a solução de um problema para a sociedade.”
O avanço, de fato, abre espaço para multiplicar os caminhos e atender mais demandas. “Tem muita gente estudando a fundo o genoma”, afirma Côrtes. A redução do uso de produtos químicos na agricultura está no foco principal. Segundo o Ministério da Agricultura e Pecuária, o Brasil é líder no uso de bioinsumos, e a produção nacional cresce 30%, enquanto o avanço global é de 18%.

Para o pesquisador da Embrapa, essa representatividade pode ser até maior, caso o Brasil evolua no desenvolvimento de produtos biológicos que apresentem mais agilidade e eficiência no controle de doenças. Quanto maior a confiança do agricultor nos bioinsumos, maior a possibilidade de diminuir em escala o uso de moléculas sintéticas. “No entanto, o mais importante é fazer um manejo integrado”, diz Côrtes. “Embora já existam relatos de grandes produtores utilizando apenas biológicos, a ideia é oferecer soluções ao produtor, sem uma disputa de mercado.”
A abrangência da aplicação é outro fator favorável à expansão do uso da edição gênica na agricultura. A própria Embrapa tem diferentes pesquisas nessa frente, como a descoberta de um fator que pode potencializar a ação do Beauveria bassiana, fungo usado para o controle biológico de insetos, em especial no café. “Detectamos um fator de virulência que pode ser melhorado geneticamente”, afirma Côrtes. Esse estudo ainda precisa avançar, pois o fungo tem um gene exógeno que
pode classificar a edição como transgenia.
Outra linha de pesquisa é de fixação de nitrogênio para o feijão, que a planta até já realiza de forma natural, mas sem a mesma eficiência da soja. Por isso, acaba sendo feita artificialmente, para chegar aos níveis ideais. O objetivo é cortar caminho para chegar nesse patamar. No caso da Sempre AgTech, a forte aposta na edição gênica é bastante direcionada para o milho, cultura que representa o principal mercado da empresa. E em parceria com a Embrapa.
O foco é aumentar a eficiência das plantas na utilização do nitrogênio, reduzindo a demanda pelo insumo. “Gramíneas demandam muito nitrogênio, que geralmente é fóssil. Beneficiaremos o produtor e o meio ambiente”, diz Molinari. Diferentemente do que acontece com a soja, o processo é a adição de uma bactéria para que faça a conversão do nitrogênio atmosférico, deixando-o disponível para a absorção pela planta. Também há a edição do milho para que seja mais eficiente.
A Sempre AgTech trabalha ainda para dar status
O Brasil já é um dos maiores mercados do mundo em atividades ligadas ao uso da edição genética em microrganismos

de sniper à proteção de cultivos por pulverização.
A partir de informações de RNA, a empresa procura desenvolver uma molécula biológica que atinja especificamente aquela praga que se pretende combater. “É muito pontual, precisa, vai atacar apenas aquela praga distinta. É uma ferramenta poderosíssima para desligar genes”, diz Molinari.
O desenvolvimento já está avançado para alguns alvos, principalmente aquelas mais problemáticas. O desafio agora é descobrir como desenvolver a molécula em grande escala com custo baixo. E torná-la mais resistente, com formulações que garantam mais durabilidade nas plantas. O aprimoramento nessa área de edição gênica pode ser uma saída inclusive para problemas regionais, com pragas que atacam um tipo específico de cultura em uma determinada localidade. “A ferramenta democratiza a tecnologia, a ciência, pois não demanda custos tão altos como a transgenia, e já há massa crítica”, analisa Molinari. “É uma evolução silenciosa.”
O cenário favorece o ritmo das pesquisas nesse campo. O Brasil já é o nono mercado mais procurado para a proteção de patentes relacionadas a CRISPR. E ocupa a 28ª posição na lista dos países desenvolvedores. Ou seja, há muito espaço a ser conquistado. Essas informações são do Radar Tecnológico elaborado pelo Instituto Nacional da Propriedade Industrial (Inpi), em parceria com a Embrapa. Conforme o documento, o Brasil é um importante mercado para as organizações que desenvolvem tecnologias relacionadas ao emprego do sistema CRISPR na agricultura e pecuária. O país tem tudo para seguir evoluindo nessa área, como centros de pesquisa (públicos e privados), gente capacitada e legislação avançada. Na verdade, quase tudo. “Nosso maior gargalo é financiamento para pesquisa”, afirma Côrtes. “Não basta avançar, precisamos avançar rápido, por isso é importante ter a tranquilidade do financiamento com recurso público, de forma segura, sem interrupções.”




Em sua 6ª edição, o DATAGRO Abertura de Safra – Soja, Milho e Algodão consolida-se como referência no calendário do agronegócio, reunindo mais de 500 participantes em Goiânia para marcar o início do ciclo 2025/26
P or r onaldo l uiz










Pela primeira vez, Goiânia (GO) sediou o DATAGRO Abertura de Safra – Soja, Milho e Algodão, evento que se consolida, ano após ano, como o ponto de partida para a nova safra de grãos que se aproxima. Organizado pela DATAGRO, o encontro chegou em 2025 a sua 6ª edição, reunindo mais de 500 pessoas no centro de convenção do World Trade Center da capital de Goiás, reafirmando a jornada de integração virtuosa entre as cadeias produtivas do agronegócio brasileiro. Segundo o anfitrião do evento, o presidente da DATAGRO, Plinio Nastari, a conexão entre grãos, fibras, carnes, cana e biocombustíveis é um diferencial do Brasil e um exemplo real de industrialização do setor agro nacional. “O cultivo de grãos está na base dos biocombustíveis, com a soja no biodiesel, o milho no etanol, e também com os óleos vegetais, o farelo e o DDG, que são insumos para frangos, suínos e bovinos, num processo que resulta no crescimento de nossas exportações de carnes”, disse na cerimônia de abertura.
A evolução, ressaltou Nastari, foi planejada com a incorporação de tecnologias e novos modelos de negócios que vêm gerando desenvolvimento para o País. De acordo com Nastari, a agenda de transformação reforça, uma vez mais, o papel do Brasil para a segurança alimentar e energética global: “Precisamos que a atividade agropecuária seja reconhecida e valorizada”. O presidente da DATAGRO mencionou ainda a importante contribuição do agro como sumidouro de carbono, por meio do amplo conjunto de boas práticas implementadas pelo setor.
Também presente na solenidade de abertura, o secretário de Agricultura, Pecuária e Abastecimento de Goiás, Pedro Leonardo Rezende, que representou o governador Ronaldo Caiado, ressaltou o potencial do agronegócio goiano, que vem se diversificando de maneira acentuada nos últimos anos, inclusive com a viabilização de novas regiões produtoras, em especial o Vale do Araguaia. A cerimônia de abertura contou ainda com a presença do presidente da Federação das Indústrias do Estado de Goiás (Fieg), André Rocha; do diretor superintendente do Sebrae-GO, Antônio
Carlos de Souza Lima Neto; do presidente da Federação da Agricultura e Pecuária de Goiás (Faeg) e vice-presidente da Confederação da Agricultura e Pecuária do Brasil (CNA), José Mário Schreiner; e da deputada federal Marussa Boldrin. Confira os principais destaques do evento.
Às vésperas da safra de verão 2025/26, o cenário é de otimismo moderado. A expectativa inicial aponta para expansão da área plantada, ganhos de produtividade e colheita cheia. O entusiasmo, porém, convive com desafios importantes: preços acomodados das principais commodities, sobretudo soja e milho, e custos de produção em patamares mais altos. Esse foi o quadro traçado por especialistas reunidos no painel 1. “Ainda atravessamos um ciclo de baixa nas cotações, com valores apertados e custos maiores, então a safra nova será mais desafiadora que a anterior”, disse o líder da DATAGRO Grãos, Flávio Roberto de França Junior.
Segundo Rafael Mingoti, supervisor de grupo de pesquisa da Embrapa Territorial, a empresa pública tem se dedicado a mapear áreas do território brasileiro com potencial de fornecer matérias-primas para a produção de fertilizantes, buscando reduzir a dependência externa desses insumos. No pós-colheita, porém, persiste outro desafio estrutural: a infraestrutura logística, marcada pelo déficit de armazenagem de grãos, já que a produção nacional avança em ritmo superior à capacidade de estocagem do País.
Nessa agenda, o diretor executivo da Abramilho (Associação Brasileira dos Produtores de Milho e Sorgo), Glauber Silveira, destacou o potencial do Brasil para ampliar a área cultivada por meio da recuperação de pastagens degradadas. Estima-se que cerca de 40 milhões de hectares possam ser reconvertidos para a produção agropecuária. Em Goiás, por exemplo, há aproximadamente 10 milhões de hectares com esse potencial, segundo José Mário Schreiner, presidente da Faeg (Federação da Agricultura e Pecuária de Goiás) e vice-pre-









sidente da CNA (Confederação da Agricultura e Pecuária do Brasil). Ele acrescentou, porém, que ainda persistem gargalos relacionados ao crédito e ao seguro rural.
A dependência do Brasil da importação de aproximadamente 85% das matérias-primas para a fabricação de fertilizantes é uma vulnerabilidade estrutural do agro brasileiro, alertou o diretorexecutivo da Anda (Associação Nacional para Difusão de Adubos), Ricardo Luiz Tortorella, no painel 2. “Nós importamos em torno de 41 milhões de toneladas de fertilizantes e produzimos somente 6 milhões, o que deixa o agro exposto a riscos de preços e de desabastecimento”, afirmou. Segundo Tortorella, ao depender da importação elevada,
o Brasil acaba tendo que pagar o preço que é dado pelo mercado, com pouco poder de negociação. Além disso, a dependência do insumo de fora acarreta riscos ao abastecimento, sobretudo em tempos geopolíticos conturbados como o atual.
O dirigente da Anda ressaltou que o cenário precisa mudar, mas ainda falta impulso: comercialmente, continua mais vantajoso importar fertilizantes do que investir em uma indústria nacional. “Com os riscos de desabastecimento e de alta de preços, não se pode mais esperar”, alertou. Segundo Tortorella, uma das alternativas está no Plano Nacional de Fertilizantes, que reúne uma carteira de projetos voltados a ampliar a produção doméstica: “O País tem reservas, o setor não pede subsídios, mas sim segurança jurídica para produzir com sustentabilidade. Há um empreendimento com licença ambiental que está parado há 16 anos”.






No painel moderado por Elcio Perpétuo Guimarães, chefe-geral da Embrapa Arroz e Feijão, o CEO da Agrion Fertilizantes, Ernani Judice, apresentou a empresa, especializada em adubos organominerais. A companhia adota um modelo de negócio inovador, instalando fábricas dentro das propriedades rurais. “Aproveitamos resíduos e sobras, como a vinhaça da cana, para formular nossos produtos, sempre com foco em soluções cada vez mais personalizadas”, disse.
A reforma tributária deve alterar o ambiente da indústria de processamento de grãos, e investimentos previstos a partir de 2026 podem ser diretamente afetados. Segundo o secretário de
Política Agrícola do Ministério da Agricultura e Pecuária (Mapa), Guilherme Campos, os empresários precisam acompanhar de perto o cenário, já que as vantagens tributárias hoje oferecidas pelos estados podem mudar.
Segundo Priscila Valin, presidente da Comissão de Tributação da Associação Brasileira das Indústrias de Óleos Vegetais (Abiove), a reforma tributária deve mudar a lógica das decisões no setor. “Hoje, muitos investimentos e até a instalação de plantas industriais se baseiam em incentivos fiscais”, afirmou. “Com a reforma, a vantagem competitiva deixará de vir do benefício tributário e passará a ser determinada pela eficiência.”
O painel “Integração das cadeias de grãos e









pecuária: geração de valor e novos mercados” enfatizou a crescente conexão entre agricultura e bovinocultura. “A pecuária atravessa um período de forte intensificação, sem estar mais ancorada na abertura de novas áreas”, ressaltou o líder da Área de Pecuária da DATAGRO, João Otávio Figueiredo. “Essa transformação inclui uso de dados para tomada de decisão, processos de rastreabilidade, aproveitamento cada vez maior de resíduos agrícolas como insumos para alimentação animal, diversificação de culturas e otimização logística.”
Sérgio Pellizzer, CEO da Fazenda Conforto, e Thiago Amorim, diretor de Pecuária da Agrojem, apresentaram as suas propriedades como exemplos da integração lavoura-pecuária. Nesse modelo, a pecuária também fornece dejetos, que funcionam como matéria-prima para a produção de fertilizantes para agricultura.
Na década de 1960, o algodão representava cerca de 70% da matéria-prima utilizada pela indústria têxtil mundial, com as fibras sintéticas respondendo por apenas 30%. De lá para cá, o percentual se inverteu. Foi com esse recado que o diretor da Valença Têxtil, Sérgio Armando Benevides Filho, abriu o painel sobre a cotonicultura.
As fibras sintéticas, derivadas do petróleo, avançam na indústria têxtil mundial sobretudo pelo menor custo. Para recuperar espaço, o algodão precisa reforçar atributos que vão além do preço, como qualidade e sustentabilidade. A grande transformação ocorreu no campo da produção: o Brasil deixou de ser importador para se tornar o maior exportador mundial de algodão. No ano comercial 2023/24, encerrado em






julho, o País embarcou 2,7 milhões de toneladas da fibra, um salto de 85% em relação à safra anterior, superando os Estados Unidos e assumindo a liderança global.
A despeito de importantes avanços nos últimos anos, a infraestrutura logística de transporte e armazenagem não acompanha a evolução do agro brasileiro. “Atualmente, mais de 80% da soja e do milho ainda são transportados por rodovias, o que eleva os custos”, disse a representante da Confederação da Agricultura e Pecuária do Brasil (CNA), Elisangela Pereira Lopes. “O frete rodoviário de Sorriso (MT) até a China, por exemplo, representa US$ 25 de um total de US$ 126 por tonelada exportada. Alternativas como ferrovias e
hidrovias poderiam reduzir essa relação.”
Segundo Gabriel Fonseca, executivo da VLI Logística, os modais de transporte ainda apresentam forte desbalanceamento. Entre os avanços, destacou o aumento dos embarques pelos portos do Arco Norte. Já o presidente da Autoridade Portuária de Santos (APS), Anderson Pomini, anunciou investimentos de R$ 12,5 bilhões previstos para o terminal nos próximos anos.
O diretor da Conab, Thomé Luiz Guth, chamou a atenção para o déficit de armazenagem agrícola. “No Mato Grosso, por exemplo, a capacidade estática que em 2010 atendia 92% da produção hoje cobre apenas 42%, e esse cenário se repete em outros importantes estados produtores”, afirmou. Para reverter o quadro, Guth defendeu a adoção de políticas públicas de apoio ao produtor.
O Programa Nacional do Álcool (Proálcool), criado em 1975, completa meio século de existência. Ao longo desse período, consolidou-se como uma das políticas públicas mais relevantes da história do Brasil, transformando a cana-de-açúcar em vetor estratégico para a segurança energética, para a diversificação da matriz e para o fortalecimento da agroindústria.
O Proálcool nasceu em um contexto de grande incerteza. O presidente Ernesto Geisel compreendia a vulnerabilidade do País diante da dependência externa de petróleo e antevia os riscos da volatilidade dos preços do açúcar no mercado internacional, que já havia oscilado de US$ 0,05 para US$ 0,50 por libra-peso em função de medidas protecionistas e eventos geopolíticos, como o embargo a Cuba. Foi essa visão estratégica que
impulsionou a decisão de estimular a produção de álcool combustível como alternativa complementar à gasolina.
A trajetória do programa não foi linear. O período de crises entre 1989 e 1990 é lembrado por acusações de que usinas teriam retido álcool para priorizar a produção de açúcar. Na realidade, as cotas definidas pelo Instituto do Açúcar e do Álcool (IAA) eram rigorosamente cumpridas pelas usinas, e o desabastecimento resultou de falhas de gestão e coordenação estatal. Todas as crises do Proálcool, como a experiência demonstrou, foram fabricadas.
O setor sucroenergético, por sua vez, demonstrou enorme resiliência.
A cada momento de retração, a indústria respondeu com eficiência, tecnologia e capacidade de adaptação. Foi assim que, a partir da década
de 2000, o Brasil consolidou-se como o maior produtor mundial de açúcar e o segundo maior produtor de etanol, exportando tecnologia e know-how em biocombustíveis.
Nos anos iniciais do Proálcool, a produção de etanol combustível era modesta, pouco acima de 600 milhões de litros. Hoje, essa marca foi multiplicada por mais de 50 vezes. Na safra 2025/26, a moagem de cana para uso industrial deve atingir 664 milhões de toneladas de cana, produzindo estimados 44,85 milhões de toneladas de açúcar e 36,2 bilhões de litros de etanol, dos quais 26 bilhões de litros de etanol de cana e 10,2 bilhões de litros de etanol de milho. Essa escala expressiva, construída em cinco décadas, demonstra o salto tecnológico e produtivo proporcionado pelo programa.
Esse avanço reflete também a impressionante produtividade da cana-de-açúcar, que no Brasil atinge rendimentos acima de 70 toneladas por hectare. A integração agrícola-industrial entre a cana e o milho, e a diversificação crescente da produção, gerando coprodutos como a bioeletricidade, o biogás e biometano, as leveduras, o etanol de segunda geração, o DDG/DDGS na cadeia do etanol de milho, e a captura de CO₂ biogênico fazem da cadeia sucroenergética uma das mais eficientes do mundo.
No cenário internacional, o Brasil responde por cerca de 50% do açúcar exportado globalmente e figura entre os maiores exportadores de etanol, consolidando-se como referência em biocombustíveis. Esses resultados reforçam a importância do Proálcool como base de uma estratégia de longo prazo que alia competitividade e sustentabilidade. A cana de açúcar se consolidou como a fonte de energia mais importante da oferta interna de energia, com 16,7% do total, que em 2024 atingiu 50% de renováveis. No primeiro semestre de 2025, o etanol
combustível substituiu 45,6% de toda a gasolina consumida no Brasil, uma marca inigualada em todo o mundo, e que serve de modelo para muitos outros países como EUA, Índia, Tailândia, Indonésia, Paraguai, Argentina e Bolívia, dentre outros. Os benefícios ambientais também são significativos. O etanol brasileiro reduz em até 90% as emissões de gases de efeito estufa em relação à gasolina, e o uso do combustível já evitou a emissão de centenas de milhões de toneladas de CO₂ ao longo de sua trajetória. Trata-se, portanto, de um exemplo de política pública que antecipa soluções para a agenda climática contemporânea.
A experiência do Proálcool, iniciada há 50 anos, permitiu a criação de um arcabouço institucional robusto, que sustenta a política de biocombustíveis até hoje e serviu de base para programas subsequentes, como o RenovaBio, a Lei Combustível do Futuro, o Programa de Aceleração da Transição Energética e o Programa Mover.
Celebrar os 50 anos do Proálcool é reconhecer
a importância de políticas de Estado que transcendem governos, que criam condições para a inovação e que projetam o Brasil como referência mundial em energia renovável. Mais do que um capítulo da nossa história, o Proálcool permanece como uma bússola para o futuro: mostra que é possível, com visão estratégica, transformar vulnerabilidades em oportunidades e construir caminhos de sustentabilidade e segurança energética.
E é justamente com esse espírito de celebração que os 50 anos do Proálcool serão celebrados na 25ª Conferência Internacional DATAGRO sobre Açúcar e Etanol, a ser realizada nos dias 20 e 21 de outubro, em São Paulo. O evento reunirá lideranças do setor, autoridades e especialistas para discutir o legado do programa e projetar os próximos passos da transição energética.
